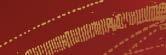

Juli 2023 Offizieller monatlicher Veranstaltungskalender für Erfurt www.erfurt-magazin.info


















































30. DOMSTUFEN-FESTSPIELE IN ERFURT Sommerliches Musiktheater vor historischer Kulisse

Die DomStufen-Festspiele in Erfurt sind aus dem Veranstaltungskalender der Thüringischen Landeshauptstadt nicht mehr wegzudenken. Jeden Sommer verwandelt das Theater Erfurt die 70 Stufen der historischen Kulisse aus Dom und Severikirche in eine opulente Opern- oder Musicalbühne und hat damit bisher hunderttausende Besucher erreicht. Längst kommen die Gäste nicht mehr nur aus Deutschland, sondern auch aus vielen europäischen Nachbarländern, den USA, Brasilien, China und Australien. Das verwundert nicht, liegt doch das Festspiel-Areal inmitten der wunderschönen Erfurter Altstadt, die im Sommer mediterranes Flair versprüht und mit vielen Cafés und Restaurants auch kulinarisch einiges zu bieten hat. Seit 2003 tragen die Festspiele die Handschrift von Generalintendant Guy Montavon, unter dessen Leitung die Besucher unvergessene Inszenierungen und Uraufführungen erleben durften. Die hohe Nachfrage spricht für die künstlerischen Leistungen des Theaters Erfurt und hat in den vergangenen Jahren zu einer Erweiterung des Platzangebotes auf der Zuschauertribüne und zu einer Ausweitung der Aufführungstermine geführt. Von Beginn an werden die DomStufen-Festspiele von der Sparkassen-Finanzgruppe Hessen-Thüringen als Generalsponsor gefördert und begleitet.
30. DomStufen-Festspiele in Erfurt 2023:
Bühnenwerk von Hector Berlioz
Premiere: 07.07.2023
Weitere Vorstellungen: 08.07. – 30.07.2023
Jim Knopf und Lukas der Lokomotivführer
Wiederaufnahme: 15.07.2023
Weitere Vorstellungen: 15.07. – 27.07.2023
Wenn Sie Informationen zu Ihren Veranstaltungstickets erfahren möchten, wählen Sie bitte die Ticket–Hotline
Tel. 0361/ 66 40 100.
IMPRESSUM
Herausgeber: Erfurt Tourismus und Marketing GmbH, Benediktsplatz 1, Tel. (0361) 66 40–0, Fax 66 40–290
Redaktion: Mathias Kabisch, Tim Stange Erfurt Tourismus und Marketing GmbH, Benediktsplatz 1, Tel. (0361) 66 40–241, Fax 66 40–299, events@erfurt-tourismus.de
Redaktionsschluss: 14.06.2023
Layout und Anzeigen: www.kleinearche.de, Werbeagentur Kleine Arche GmbH, Holbeinstr. 73, 99096 Erfurt, Tel. (0361) 7 46 74 –80, Fax –85
Anzeigenleitung: Werbeagentur Kleine Arche GmbH, Tel. (0361) 7 46 74 –80, Fax –85 (z. Zt. gilt die Anzeigenpreisliste seit 25.11.2022)
Druck: Druckhaus Gera GmbH
Fotos: Sofern nicht anders angegeben, liegen die Bildrechte bei den Künstlern und Agenturen.
Stadtplan: mr-Kartographie – Ingenieurbüro und Verlag
Einzelvertrieb: Erfurt Tourismus und Marketing GmbH, Benediktsplatz 1, Tel. (0361) 66 400, Bezugspreis jährlich: 19,80 Euro incl. 7 % MwSt. Abonnieren unter www.erfurt-magazin.info
Auflage: 10.000 Exemplare
Alle Informationen wurden mit größter Sorgfalt aufgenommen, sind jedoch ohne Gewähr. Änderungen vorbehalten!
3 JuliINHALT
HIGHLIGHTS 4 AUSSTELLUNGEN 10 – 12 TERMINE 14 – 53 INNENSTADTPLAN 36 – 37 LINIENNETZ ÖPNV 38
VERANSTALTUNGSORTE 70
VORSCHAU 2023/24 ab S. 56
VORSCHAU 2023
1.7.2023
Petersbergfest Zitadelle Petersberg hm
1. – 2.7.2023
Kreativgarten Festival egapark
7. – 30.7.2023
DomStufen-Festspiele: Fausts Verdammnis
Domplatz
15. – 27.7.2023
Domino: Jim Knopf und Lukas der Lokomotivführer Domplatz
27.7. – 27.8.2023
Der Menschenfeind Barfüßerruine
4. – 6.8.2023
Típica Festival Innenstadt

11. – 12.8.2023
Lichterfest egapark
26. – 27.8.2023
Thüringer Gartentage egapark
1.9.2023
Goldenes Rad von Erfurt
Radrennbahn Andreasried
2.9.2023
Pyro Games Messe Erfurt
5. – 10.9.2023
Denkmaltage Erfurt 2023 Innenstadt

7. – 10.9.2023
Erfurter Weinfest Domplatz
16. – 24.9.2023
Erfurter Kirchenmusiktage Innenstadt
22.9. – 8.10.2023
Erfurter Oktoberfest Domplatz
1.10.2023
Heimat shoppen (und verkaufsoffener Sonntag)
Innenstadt
31.10.2023
KürbisErnteFest egapark
10.11.2023
Ökumenisches Martinsfest Domplatz
28.11. – 22.12.2023
173. Erfurter Weihnachtsmarkt Domplatz
5.12.2023
Night of the Proms Messe Erfurt
4
Juli HIGHLIGHTS
Foto: Stadtverwaltung Erfurt
DONAUdelta Amazonas Europas
MIT AUFNAHMEN VON CHRISTOPH ROBILLER

NATURKUNDEMUSEUM ERFURT
FAUSTS VERDAMMNIS
La Damnation de Faust

30. DomStufen-Festspiele in Erfurt 2023
Bühnenwerk von Hector Berlioz
Premiere: Freitag, 07.07.2023, 20.30 Uhr
Musikalische Leitung: Yannis Pouspourikas
Regie und Ausstattung: Ben Baur h
Das Bühnenwerk des französischen Komponisten Hector Berlioz ist eine einzigartige musikalische Interpretation der klassischen Tragödie von Goethes Faust über den Gelehrten Dr. Heinrich Faust, der seine Seele dem Teufel verkauft. So frei Berlioz mit dem Handlungsgerüst von Goethes Dichtung auch umging, dem Geist des Werkes fühlte er sich verpflichtet.
Regisseur und Ausstatter Ben Baur inszeniert die „dramatische Legende“ Fausts Verdammnis als ein wahres Gesamtkunstwerk, bei dem der Dom zum Mitspieler wird und unglaublich schöne Musik stimmungsvolle Bilder erzeugt. Ein grandioses Philharmonisches Orchester Erfurt, internationale Solisten und ein Chor mit über 65 Personen erzeugen zusammen eine außergewöhnliche Klangvielfalt mit emotionalem Tiefgang. Hinzu kommen atemberaubende Akrobatikeinlagen vor mystischer Kulisse und eine tanzende Teufelstruppe als Erweiterung der Mephisto-Rolle.
JIM KNOPF
und Lukas der Lokomotivführer
Domino – DomStufen-Festspiele für die Kleinen 2023

Musiktheater von Tobias Rokahr
Text von Katharina Tarján nach Michael Ende Wiederaufnahme: Samstag, 15. Juli 2023, 11 Uhr h
Die winzige Insel Lummerland ist die Heimat von Lukas, dem Lokomotivführer, und seiner treuen Lok Emma. Und natürlich von Jim Knopf, der als Baby per Postpaket auf der Insel gelandet ist. Jim und Lukas sind die allerbesten Freunde. Gemeinsam mit der Lokomotive Emma fahren sie ihre Runden rund um die winzige Insel mit zwei Bergen. Als es auf Lummerland plötzlich zu eng wird, machen sie sich gemeinsam mit ihrer Lokomotive auf die Suche nach einer neuen Heimat.
Michael Endes Jim Knopf – ein vielfach ausgezeichneter, in dreißig Sprachen übersetzter Jugendbuch-Klassiker – und nun, nach Hörspiel, Marionettentheater, Schauspieladaptionen, Musical und Film auch noch als Oper? Aber ja, unbedingt! Wie keine andere Kunstform beherrscht die Oper die Balance zwischen dem Komischen und dem Erhabenen, der Unterhaltung und dem tiefen Sinn, der Opulenz und der Schlichtheit zeitloser Wahrheiten.
Weitere Termine: 16.07.2023, 10 Uhr und 14 Uhr I 19.07.2023, 10 Uhr 22.07.2023, 10 Uhr und 14 Uhr I 23.07.2023, 10 Uhr 27.07.2023, 10 Uhr
6
Juli HIGHLIGHTS
Weitere Termine: 08.07. I 09.07. I 11.07. I 12.07. I 13.07. I 14.07. I 15.07. 16.07. I 18.07. I 19.07. I 20.07. I 21.07. I 22.07. I 23.07. 26.07. I 27.07. I 28.07. I 29.07. I 30.07.2023
Foto: Lutz Edelhoff
Foto: Lutz Edelhoff
SOMMER IM THEATRIUM
Eine musikalische Entdeckungsreise unter freiem Himmel
h
Am 2. Juli 2023 um 11 Uhr stellen die Akademist:innen des Philharmonischen Orchesters Erfurt in der Sommerkonzertreihe Sommer im Theatrium ihre persönlichen Lieblingsstücke vor. Beim Auftritt der Band Holger-ArndtConnexion am 8. Juli 2023 um 18 Uhr können Sie sich auf einen Mix aus Jazz und Swing freuen. Das Repertoire der 1998 gegründeten Band umfasst groovende Cover-Versionen moderner Stücke bis hin zu Klassikern und eigenen Arrangements. Zum Abschluss treffen am 14. Juli 2023 um 18 Uhr zwei weitere Kammermusikensembles zusammen, die mit Stücken des Barocks bis hin zur Musik der Gegenwart die Zuhörerschaft stimmungsvoll in den Sommer begleiten.

Wir freuen uns auf Ihren Besuch im Innenhof des Theaters Erfurt – und bei schlechtem Wetter finden die Vorstellungen in der STUDIO.BOX statt.
TAG DER OFFENEN TÜR
am Theater Erfurt


23. September 2023
h
20. Jahre Theater Erfurt. Ein besonderes Jubiläum, welches wir gern mit Ihnen gemeinsam feiern möchten. Dazu laden wir Sie herzlich am 23. September 2023 in der Zeit von 11 bis 17 Uhr zu unserem Tag der offenen Tür ein.
Passend zu unserer neuen Spielzeit unter dem Motto „UFERLOS“ entführen wir Sie in die Welt des Wassers. Werfen Sie einen Blick vor und hinter die Kulissen und erkunden Sie unsere Werkstätten, in denen sich nach 20 Jahren so einiges angesammelt hat. Lernen Sie die Mitarbeiter:innen unseres Hauses beim SpeedDating in einem ungezwungenen Gespräch kennen und erfahren Sie aus erster Hand von den vielseitigen Ausbildungsmöglichkeiten am Theater. Bummeln Sie über unseren Flohmarkt und ersteigern Sie ein neues Kostüm für die nächste Faschingsfeier. Ein Tag für die ganze Familie. Wir freuen uns, Sie in unserem Haus begrüßen zu können!
Alle Tickets für Veranstaltungen sind auch in der ERFURT TOURIST INFORMATION am Benediktsplatz 1 (zwischen Rathaus und Krämerbrücke) erhältlich – Tel. 0361/66 40 100.

7 Juli HIGHLIGHTS
Foto: Band Holger-Arndt-Connexion
Foto: ETMG, B. Neumann
Foto: Theatrium, Theater Erfurt
Juli HIGHLIGHTS
RENNSTEIG-SHUTTLE
Direktverbindung
zwischen Erfurt und Rennsteig!
Von Erfurt aus haben Sie die Möglichkeit, schnell und bequem mit der Erfurter Bahn Deutschlands ältesten und beliebtesten Höhenwanderweg zu erreichen. Mitten im UNESCO Biosphärenreservat Vessertal-Thüringer Wald lädt die herrliche Landschaft zu jeder Jahreszeit zu vielen Unternehmungen ein: Wandern, geführte Touren, Radeln, Skilaufen, Kutsch- und Pferdeschlittenfahrten, Mountainbiken, Geocaching und vieles mehr!


www.erfurter-bahn.de
PETERSBERGFEST
1. Juli 2023, 10–18 Uhr

Über der Erfurter Altstadt erhebt sich die Zitadelle Petersberg – eine der größten und einzige weitgehend erhaltene barocke Stadtfestung Mitteleuropas. Seit 1990 wird sie mit viel Liebe zum Detail und großem Aufwand rekonstruiert.
Bei einem Besuch der Zitadelle können Sie die neue Ausstellung im Kommandantenhaus sowie die Horchgänge in den starken Mauern der Festung erkunden oder einfach nur den traumhaften Ausblick über die Altstadt genießen.
Am 01. Juli laden verschiedene Partner der Zitadelle Petersberg Klein und Groß mit vielfältigen Angeboten auf dem gesamten Festungsgelände zum gemeinsamen Petersbergfest ein.
Ganztägig können sich Jung und Alt auf ein Veranstaltungsprogramm freuen, bei dem es jede Menge zu erleben, auszuprobieren und zu genießen gibt.
Für Speis und Trank sorgen an diesem Tag verschiedene gastronomische Partner. Der Eintritt ist frei!
www.petersberg-erfurt.de
 Foto: ETMG, S. Bauerschmidt
Foto: ETMG, S. Bauerschmidt
Foto: ETMG, S. Bauerschmidt
Foto: ETMG, S. Bauerschmidt
Wir freuen uns auf Ihren Besuch!
Foto: Erfurter Bahn
31. WEINFEST
7. bis 10. September 2023
Einmal im Jahr laden Winzer verschiedener Anbaugebiete in die romantische Altstadt von Erfurt ein, um bei einem guten Tropfen, gediegenen Speisen und toller Musik zu feiern.
Winzer aus unterschiedlichen Weinanbaugebieten Deutschlands bringen die besten Tropfen aus ihren Weinkellern mit in die alte Weinstadt Erfurt.

Wenn es auch kaum noch vorstellbar ist, so wurde im Mittelalter in Erfurt viel Wein angebaut. Über die Stadt schreibt ein Chronist im Jahre 1161 „Anhöhen um Erfurt herum, selbst die nördlich gelegene, der alte Steiger, waren mit Weinbergen bedeckt“.
Den ältesten Nachweis über den Weinanbau liefert eine Urkunde aus dem Jahre 1121, in welcher der Probst des Severistiftes Anordnungen zur Verpflegung erteilt.
Aber auch heute noch sind die Erfurter dem Wein zugetan. Die ideale Gelegenheit dazu bietet das Weinfest, welches gute Musik und guten Wein miteinander verbindet.
Am Samstag und Sonntag wird das Weinfest vom 30. Kunst- und Kreativmarkt umrahmt. An beiden Tagen haben Künstler, Kunsthandwerker sowie Hobbykünstler im malerischen Ambiente der Erfurter Altstadt ihre Stände aufgebaut.
Der Eintritt ist kostenfrei!
www.erfurt.de
Augustinerstraße 10 99084 Erfurt
Telefon: 03 61 57 66 0 - 0
Mehr Informationen unter: www.augustinerkloster.de
2.7. | 17 Uhr
Sonntagskonzert: Augustiner-Vocalkreis Werke von Schütz, Brahms und Pärt
3.7. | 19 Uhr
Geistige und leibliche
Genüsse – Vortrag: „Orte der Spiritualität“, dazu ein rätselhafter Imbiss und eine schleierhafte Bowle
16.7. | 9.30 – 15 Uhr
Rosenfest zum Jahrestag von Luthers Eintritt ins Kloster mit Festgottesdienst in der Rosenkirche, Führungen durch Kloster, Elisabethkapelle und Bibliothek, Harfenmusik, Aktionen rund um die Rose für Jung und Alt, kulinarischen Genüssen und Rosenbowle
Gebetszeiten in der Augustinerkirche täglich, 12 Uhr (außer sonntags) und 18 Uhr
jeden Freitag Friedensgebet
12 Uhr – Ort der Stille Abendmahlsgottesdienst jeden Sonntag und Feiertag, 9.30 Uhr
Weitere Einzelheiten entnehmen Sie bitte der Tagespresse oder unter
www.augustinerkloster.de
im Stadtplan: C2
9 Juli HIGHLIGHTS
Foto: Matthias Frank Schmidt
AUGUSTINERKLOSTER ZU ERFURT
Angermuseum
Anger 18, Tel. 6 55 16 51, Di – So 10 – 18 Uhr
2.7.–24.9.23: De Ploeg – Avantgarde in den Niederlanden
Alte Synagoge
Waagegasse 8, Tel. 6 55 15 20, Di – So 10 – 18 Uhr
Zeugnisse der Kultur und Geschichte der jüdischen Gemeinde Erfurts im Mittelalter
bis 7.1.24: In and Out – Between and Beyond: Jüdisches Alltagsleben im mittelalterlichen Europa
Kleine Synagoge
An der Stadtmünze 4 – 5, Tel. 6 55 16 66, Di – So 11 – 18 Uhr
Dauerausstellung: Jüdisches Leben in Erfurt im 19. und 20. Jahrhundert
Naturkundemuseum g
Große Arche 14, Di – So 11 – 18 Uhr
bis 19.11.23: Das Donaudelta – Amazonas Europas
Kulturhof Krönbacken/Galerie Waidspeicher

Michaelisstr. 10, Di – So 11 – 18 Uhr
bis 10.9.23: Plamen aus Plastik – Sommer, Sonne, soziale Ungerechtigkeit
Erinnerungsort Topf & Söhne
Sorbenweg 7, Di – So 10 – 18 Uhr, Tel. 6 55 16 81
Ausstellung „Techniker der Endlösung“
Topf & Söhne – „Die Ofenbauer von Auschwitz“ bis 19.5.24: Miriams Tagebuch –Die Geschichte der Erfurter Familie Feiner
Stadtmuseum
Johannesstr. 169, Tel. 6 55 56 51, Di
So 10
Rebellion – Reformation – Revolution
18 Uhr
Ein Geschichtslabor für Erfurt mit multimedialen Angeboten zur Stadtgeschichte ab 7.7.23: Entfesselt – Das 150jährige Jubiläum der Entfestigung Erfurts
Museum für Thüringer Volkskunde
Juri–Gagarin-Ring 140a, Di – So 10 – 18 Uhr bis 3.3.24: SCHWEINsKRAM –
Ein besonderes Tier im Spiegel der Privatsammlung Eberhard Frank
Benaryspeicher/Druckereimuseum
Tel. 0361–6555621/Voranmeldung: restaurierungswerkstaetten@erfurt.de bis 18.8.23: Christina Simon: Travel and Print
Gedenk– und Bildungsstätte Andreasstraße
Andreasstr. 37a, Tel. 2 19 21 20, Di/Do 12 – 20, Mi/Fr – So+Ft. 10 – 18 Uhr
Führungen Sa/So 14 Uhr sowie nach Anmeldung
4.7.–30.7.23: Leseland DDR
Das spektakuläre Donaudelta im Naturkundemuseum
Die Donau ist einer der größten Flüsse Europas und durchfließt mit einer Länge von über 2.000 km sechs Länder. Die Mündung ins Schwarze Meer bildet eines des größten Deltas Europas. Ein über Jahrtausende entstandenes Naturparadies, das sich bis heute durch das beständige Wirken dieses großen Stromes verändert.
Die Ausstellung zeigt diesen einmaligen Naturraum mit spektakulären Foto- und Filmaufnahmen des Naturfotografen Dr. Christoph Robiller, die die Einmaligkeit dieser eigenwilligen Landschaft vermitteln. Ergänzt durch Präparate charakteristischer Tiere des Deltas, ist die Darstellung der reichen Tierwelt in den angrenzenden Steppenflächen ein Highlight dieser Schau.

Die Ausstellung „Das Donaudelta – Amazonas Europas“ ist bis 19.11.2023 zu sehen.
www.naturkundemuseum-erfurt.de
10 Juli
AUSSTELLUNGEN
–
–
Foto: Christoph Robiller
Foto: Stadtverwaltung Erfurt, Dirk Urban
Außenstelle der Stasi–Unterlagenbehörde
Petersberg, Haus 19, Tel. 5 51 90
4.500 laufende Meter Unterlagen aus der Hinterlassenschaft der Bezirksverwaltung für Staatssicherheit Erfurt
Informations– und Dokumentationszentrum
„Sicherungsbereich DDR“ tägl. 9 – 18 Uhr bis 6.7.23: Leseland DDR


7.7.–28.9.23: Lernt polnisch
29.9.23–28.2.24: Der Weg zur Deustchen Einheit
Kunsthalle Erfurt –Haus zum Roten Ochsen
Fischmarkt 7, Tel. 6 55 56 60, Di – So 10 – 18 Uhr bis 30.7.23: Engelberg + Inszenierte Fotografie
Arbeiten von Claus Bach, Kurt Buchwald, Andrej
Glusgold, Matthias Leupold und Katharina Mayer
Petersberg – Kommandantenhaus
Petersberg 3, Mo – So 10 – 18 Uhr
Ausstellung „Der Petersberg – eine spannende Zeitreise“

Eine interaktive Zeitreise durch die wechselvolle Geschichte des Petersberges
Kunsthaus Erfurt
Michaelisstr. 34, Tel. 5 40 24 37, Di – Fr 12 – 18 Uhr
Paradiesgärten – Gartenparadiese i ehem. Klosterkirche St. Peter und Paul, Petersberg 14, Di – So 10 – 18 Uhr
Ausstellung der Stiftung Thüringer Schlösser und Gärten über die mittelalterliche Gartenkultur und höfische Gartenkunst in Thüringen

Sommerzeit im egapark!
1. & 2. Juli Kreativgarten Festival
Sommerliche Rhythmen, kreative Mitmachaktionen und ein buntes Programm für die ganze Familie, mit Salsakonzert am Samstagabend!
Di & Do, 17:30-18:30 Uhr

AOK PLUS Gesundheitsangebote im egapark
Jeden zweiten
Samstag, 15-16 Uhr Geschichten unterm Lesebaum
Sommerkino an der Parkbühne (kostenpflichtig)
8.7. Ein Mann Namens Otto 22.7. Einfach mal was Schönes

29.7. Triangle of Sadness
5.8. ELVIS
11. & 12. August Lichterfest
Zwei Sommerabende im Lichterglanz
Tickets & Infos online egaparkerfurt.de
Änderungen vorbehalten. Stand 30.5.23
11
Foto: Stiftung Thüringer Schlösser und Gärten, Philipp Hort
egapark
Gothaer Str. 38, Di – So 9 – 18 Uhr
2.9.–31.10.23: Kürbiszeit im egapark
Petersberg – Thüringer Vinarium
Petersberg 8, Mi – Sa ab 15 Uhr
Haus Dacheröden
Anger 37, Di – Fr 12 – 17/Sa 10 – 17 Uhr
bis 26.8.23: Bernd Zeißler: Ereignishorizont –Malerei, Mischtechniken & Collagen bis 12.8.23: Generation Z – Was dich bewegt!
Museum der DDR–Produkte
Heinrichstr. 94, Tel. 3 91 34 32, Mi/Do 10 – 18, Sa/So 13 – 18 Uhr
Arzneien, Ausweise, Bekleidung, Bücher, Büromaschinen, Computer, Drogeriewaren, Etiketten, Fernsehtechnik, Fotoapparate, Freizeitartikel, Garantieurkunden, Gebrauchsanweisungen, Genussmittel, Gläser, Haushaltchemie, Haushaltsgeräte, Innendekoration, Keramik, Kosmetik, Lebensmittel, Lederwaren, Leuchten, Möbel, Optische Geräte, Phonotechnik, Porzellan, Rundfunktechnik, Schmuck, Schreibwaren, Spielwaren, Sportartikel, Staatssymbole, Tapeten, Telekommunikationstechnik, Textilien, Uhren, Verbandsstoffe, Verpackungen, Werkzeuge, Zeitdokumente, Zeitschriften, Zeitungen...
Kunsthandlung Valdeig
Kettenstr. 10, Tel. 5 50 67 30, Mo – Fr 10 – 18, Sa 10 – 16 Uhr
Alt-Erfurt-Kunst
Schlossmuseum Molsdorf
Schlossplatz 6, Tel. 03 62 02/9 05 05, Di
So 10 – 18 Uhr (auch feiertags)
bis 15.10.23: Ina Hattenhauer.
Poolnudelpudelrudelstrudel –Bilder für Klein und Groß
Thüringer Zoopark
Am Zoopark 1, Tel. 6 55 41 51, tägl. März –Oktober 9 – 18, November – Februar 9 – 16 Uhr

940 Tiere in 136 Arten im größten Tierpark des Freistaates Thüringen i
Deutsches Gartenbaumuseum
Gothaer Str. 50, bis 31.10.2023 Di – So 10 – 18 Uhr Ausstellung zur fantastischen Welt des Gartenbaus i Sonderausstellung „Objekt sucht Geschichte –Eine Entdeckungsreise zum Mitgestalten“

DDR-Ausstellung DEUDERA
Salinenstr. 150 – ehem. Deutscher Hof, Mi – So/Ft. 10 – 18 Uhr
Erleben Sie eine Zeitreise in unsere alte Heimat in einer einzigartigen Ausstellung auf einer Fläche von über 500 Quadratmetern.
„Das fortschrittliche Erbe des Bauhauses in der DDR“: 100 Jahre Bauhausausstellung –100 greifbare Exponate bis 27.08.2023: Foto-Ausstellung
„Akt & Landschaft“ von Klaus Ender i
Margaretha-Reichardt–Haus
Am Kirchberg 32, auf Anfrage: Tel. 66 40 120 Haus und Werkstatt der Bauhaus– und Textilkünstlerin Margaretha Reichardt
Bartholomäusturm

Anger 52, Tel. 5 62 62 68 10, 12 und 18 Uhr tägl. automatische Bespielung, 1182 erste urkundliche Erwähnung, fünfokt., 60-Teiliges Glockenspiel (eingebaut 1979)
Heiligen Mühle
Mittelhäuser Str. 16, Tel. 73 32 97, Besichtigung nach Vereinbarung
Historische Vermahlungstechnik zur Perlgraupenherstellung aus dem 19. Jh.
12
Juli AUSSTELLUNGEN
–
Foto: Deutsches Gartenbaumuseum, Delf Zeh
Foto: Thüringer Zoopark Erfurt
Foto: Klaus Ender
Benediktsplatz 1 · 99084 Erfurt service@erfurt-tourismus.de www.erfurt-tourismus.de www.facebook.com/erfurterlebbar
TOURIST INFORMATION
Benediktsplatz 1

Öffnungszeiten: Mo – Sa 10.00 – 18.00 Uhr
So/Feiertag 10.00 – 15.00 Uhr


T. (0361) 66 40 -0 / F. -290 info@erfurt-tourismus.de
TICKET SERVICE
Öffnungszeiten: Mo – Sa 10.00 – 18.00 Uhr
T. (0361) 66 40 -100 tickets@erfurt-tourismus.de
















ZIMMERVERMITTLUNG
T. (0361) 66 40 -110 / F. -280 zimmer@erfurt-tourismus.de






STADTFÜHRUNGEN
(nähere Informationen umseitig!)


T. (0361) 66 40 -120 / F. -190 citytour@erfurt-tourismus.de
KONGRESSE/REISEPAKETE
T. (0361) 66 40 -230 / F. -199 tagungen@erfurt-tourismus.de pauschalen@erfurt-tourismus.de
TOURISMUSMARKETING




T. (0361) 66 40 -240 / F. -299 pr@erfurt-tourismus.de
ERFURTMAGAZIN


T. (0361) 66 40 -220 / F. -299 events@erfurt-tourismus.de
GESCHÄFTSFÜHRUNG
T. (0361) 66 40 -200 / F. 290 management@erfurt-tourismus.de

Rendezvous in der Mitte Deutschlands Willkommen Welcome illkommen
VORSCHAU-TIPP:
SILBERMOND
14.7.2023, 19 Uhr, Festwiese Petersberg

Eigentlich soll man bekanntlich ja aufhören, wenn es am schönsten ist. Aber warum nicht einfach bleiben? Weitermachen. Eben noch nicht gehen. Den Augenblick auskosten. Nur ein kleines bisschen noch, vielleicht auch unendlich lang. Die Augen schließen und nirgendwo anders sein wollen als voll und ganz im Hier und Jetzt. Wahrnehmen, wenn einem etwas guttut und es sich so richtig zu leben lohnt. Denn so, wie es gerade ist, wird es nie wieder werden. Mit ihrer neuen Single lassen Silbermond sich von genau diesem Gefühl leiten.
Mit „Wenn’s am schönsten ist“ starten Silbermond mit einer durch und durch positiven Botschaft ins neue Jahr. Auch musikalisch.
Auf „Wenn’s am schönsten ist“ sind Silbermond ganz bei sich. Gitarre, Bass, Schlagzeug und die Stimme von Stefanie Kloß sorgen für den Soundtrack zum Sonnenuntergang und all die guten Augenblicke, die am besten für immer bleiben sollen und schaffen einen Song, wie er auch 2023 nur von Silbermond kommen kann. Silbermond zählen seit ihrem Durchbruch zu den deutschen Top-Acts.
Tickets: (0361) 66 40 100
KULTUR
11:00 FESTUNGSBÄCKEREI: Open Air: Der Froschkönig
11:00 MERCURE HOTEL: BuchPassion 5
14:00 HAUS DACHERÖDEN: Unter der Leselampe
15:00 EGAPARK: Geschichten unterm Lesebaum
16:20
KINOKLUB: Wenzel: Glaubt nie, was ich singe (DE, 2023)
17:00 THOMASKIRCHE: Sinfoniekonzert des Akademischen Orchesters Erfurt
18:00 THEATER WAIDSPEICHER, PUPPENTHEATER: Der Meister und Margarita, ab 16 J.
18:30
19:00
19:30
19:30
KINOKLUB: 20.000 Arten von Bienen (ES, 23)
ANDREASKAVALIER: Tequila Sunset
AUGUSTINERKLOSTER: Goldstaub –Geschichten die das Herz erfreuen (Tel. 0361/66 40 100)
BARFÜSSERKIRCHE: Erfurt in Licht und Schatten (Tel. 0361/66 40 100)
19:30 DOM ST. MARIEN: Orgelkonzert
20:00
BARFÜSSERKIRCHE: Jazz Allstars: Holger Arndt Connexion & Friends
20:00 CLUB CENTRAL: Hagen Stoll Live
20:00 DASDIE LIVE: „Pretty Wo(man)“
20:00
20:30
21:00
21:00
HEILIGEN MÜHLE: Kalter Kaffee –Liedkabarett aus Thüringen
NATURKUNDEMUSEUM: Der kleine PrinzUnterwegs zu den Sternen (Tel. 66 40 120)
ANGERMUSEUM: Der Glöckner von Notre Dame (Tel. 0361/66 40 100)
KABARETT DIE ARCHE: Mann mit Grill sucht Frau mit Kohle
21:00 KINOKLUB: Vamos A la Playa (DE/CU, 2022)
22:00 KULTURHOF KRÖNBACKEN: Open Air im Krönbacken: Die Rumba-Therapie (FR, 2021)
23:00
ENGELSBURG: All you can dance

KIRCHE
11:00
18:00
18:00
18:00
AUGUSTINERKLOSTER: Lebenslust und Seelenqualen – Luther in Erfurt (Tel. 66 40 120)
AUGUSTINERKIRCHE: Abendgebet
DOM ST. MARIEN: Vesper
KAUFMANNSKIRCHE: Abendsegen und Orgelmusik
14 Juli
TERMINE
SA 1.
Foto: Lucio Vignolo
SPORT
15:00 SPORTPLATZ ESSENER STRASSE: Erfurt Indigos – Leipzig Hawks
FREIZEIT
06:30 DOMPLATZ: Frisch- und Hartwarenmarkt
08:30 MYTAOGARDEN AKADEMIE: Auszeit für Sie-Ein Geschenk an die Frau
10:00 ZITADELLE PETERSBERG: Petersbergfest f
10:00 EGAPARK: Kreativgarten Festival
10:00 MAISLABYRINTH ERFURT: Familien Tag –Alpaka Wanderung

10:00 MUSIK-ATELIER GABEL: Workshop Ukulele für Fortgeschrittene
10:00 STEIGERWALD (WALDKASINO): Sommertour – Bunte Blütenpracht auf dem Teller mit essbaren Wildpflanzen
10:15 ALTE SYNAGOGE: Öffentliche Führung
10:30 SONDERHALTESTELLE DOMPLATZ SÜD: Altstadt-Express, stündlich bis 15:30
11/15 BESUCHERZENTRUM ZITADELLE
PETERSBERG: Geheimnisvolle Wege...
11/14 ERFURT TOURIST INFO: Altstadtführung
11/14/16 SONDERHALTESTELLE DOMPLATZ SÜD: Erfurt-Tour: Fahrt mit der hist. Straßenbahn
11:45 MIKWE: Öffentliche Führung
12:30 MUSIK-ATELIER GABEL: Ukulele für Anfänger
13/14 DOMPLATZ: Kulinarische Stadtführung
„Andreasviertel-Tour“ (Tel. 0361 /66 40 100)
13:00 ERFURTER INNENSTADT: SCHAUinsFENSTER
13:30 WENIGEMARKT: Kulinarische Stadtführung
„Altstadt-Tour“ (Tel. 66 40 100), auch 14:30
14:00 DOM ST. MARIEN: Domführung
14:30 DOMPLATZ: Kulinarische Stadtführung
„Erfurt macht blau“ (Tel. 0361 /66 40 100)
15:00 DOMSCHATZKAMMER: Führung
15:00 VINARIUM: Rundgang durch die Aroma-Arena
16:00 ANGERMUSEUM: Eröffnung der Sonderausstellung „De Ploeg. Avantgarde in den Niederlanden“
16:00 ERFURT TOURIST INFO: Kurzführung
16/17 KULTURQUARTIER SCHAUSPIELHAUS: Führung durch das ehemalige Schauspielhaus
17:00 DESTILLE: Brennereiführung mit Verkostung
17:30 BESUCHERZENTRUM ZITADELLE
PETERSBERG: Funzelführung
20:00 ERFURT TOURIST INFORMATION: Romantischer Abendspaziergang…
22:00 CLUB PALAIS: Die große Ü30-Party
REGION
10:30 WASSERBURG KAPELLENDORF: Open Air: Der Froschkönig
19:00 WEIMAR/E-WERK: Der Diener zweier Herren
19:30 RUDOLSTADT/HEIDECKSBURG:
4. Schlosskonzert
20:00 RUDOLSTADT/HEIDECKSBURG: Open Air: Das Geheimnis der drei Tenöre
20:00 WEIMAR/SEEBÜHNE: Ben Harper
So. 2.7. | 17 Uhr
Konzert Psychochor
Sa. 8.7. | 21 Uhr
Sommernachtskonzert Duo Levanti Gesang und Gitarre – „Weltlieder“
So. 9.7. | 17 Uhr
Konzert Liederkreis
„Sommerwind“
Sa. 15.7. | 21 Uhr
Sommernachtskonzert Brassband Schnaftl Ufftschik
Kirchenweltmusik –„Ein Rausch der Sinne“
So. 16.7. | 15 Uhr
Konzert Kammermusikverein Schuberts „Forelle“ und andere klassische Kostbarkeiten
Sa. 22.7. | 21 Uhr
Sommernachtskonzert Esther Kirsch
Gesang und Gitarre –„Liebe und Leidenschaft“
Sa. 29.7. | 21 Uhr
Sommernachtskonzert
Vinzenz Heinze | „Lieblingslieder“
Mi. 16.8. | 19.30 Uhr
Theater Seibt | „Bach war nie hier…“
Fr. 18.8. | 19.30 Uhr
Theater Seibt | „Bach war nie hier…“
Sa. 19.8. | 19.30 Uhr
Theater Seibt | „Bach war nie hier…“
Sa. 26.8. | 21 Uhr
Sommernachtskonzert
Alexander Voynov
Knopfakkordeon – „Klassik einmal anders“
weitere Informationen, Preise und Tickets unter:
15 JuliTERMINE
SA 1.
www.kaufmannskirche-erfurt.de
in
Kaufmannskirche im Juli/August
Veranstaltungen
der
VERANSTALTUNGS-TIPP:
SUP ALPS TROPHY
2.7.2023, 10–17 Uhr, Lago di Alpi
Die SUP Alps Trophy ist eine legendäre Rennserie, die seit 2014 Paddler aus vielen Nationen anzieht. Die Tourstopps sind immer eine Reise wert, denn das traumhafte Ambiente aus dem Farbspiel der Seen vor und in den Alpen ist einzigartig.
In diesem Jahr hat die Rennserie einen Event aufgenommen, der weit weg der Alpen liegt: den Lago di Alpi. Dieser See und das Eventgelände vom aqua-FUN Wassersportcenter Erfurt bringen alles mit, um ein echter SUP Alps Trophy Klassiker zu werden.

In der Mitte Deutschlands treffen sich am 2. Juli bis zu 90 Paddler aus dem Norden und Osten. Zuschauer sind herzlich eingeladen!
KULTUR
11:00 STADTGARTEN: Open Air: Dornröschen
11:00 THEATER/THEATRIUM: Akademiekonzert



11:00 THEATER WAIDSPEICHER, PUPPENTHEATER: Der standhafte Zinnsoldat, ab 6 J.
15:00 ZOOPARK: Kindertheater im Zoopark
16:00 BARFÜSSERKIRCHE: Froschkönig
16:20 KINOKLUB: Wenzel: Glaubt nie, was ich singe
17:00 KAUFMANNSKIRCHE: Konzert Psychochor
17:00 REGLERKIRCHE: Chorkonzert:
Neuer Magdeburger Kammerchor
18:30 KINOKLUB: 20.000 Arten von Bienen (ES, 23)
20:00 BARFÜSSERKIRCHE: Romeo und Julia
21:00 KINOKLUB: Vamos A la Playa (DE/CU, 2022) KIRCHE
08:00
09:30
11/18
10:00 ALPERSTEDTER SEE: SUP Alps Trophy f





FREIZEIT
08:30 MYTAOGARDEN AKADEMIE: Auszeit für Sie-Ein Geschenk an die Frau
EGAPARK ERFURT: Kreativgarten Festival MAISLABYRINTH: 15 Jahre Maislabyrinth & Kinderfest mit Alpaka Wanderung h
SUP ALPS Trophy 02.07.2023


Sonntag 10-17 UHR
Lago di Alpi
Erfurt
Anmeldung: www.sup-alps-trophy21.com



11/15
SONDERHALTESTELLE DOMPLATZ SÜD: Altstadt-Express, stündlich bis 15:30
BESUCHERZENTRUM ZITADELLE
PETERSBERG: Geheimnisvolle Wege...
11/14 ERFURT TOURIST INFO: Altstadtführung
11/14
13/14
SONDERHALTESTELLE DOMPLATZ SÜD:
Erfurt-Tour: Fahrt mit der hist. Straßenbahn
DOMPLATZ: Kulinarische Stadtführung
„Historische Sonntags-Tour“ (Tel. 66 40 100)




















14:00 DOM ST. MARIEN: Domführung
15:00
16:00
17:30
KLEINE SYNAGOGE: Öffentliche Führung
STADTFARM AM KONTOR: Führung

BESUCHERZENTRUM ZITADELLE
PETERSBERG: Funzelführung
16 JuliTERMINE SO 2.
CRUCISKIRCHE
Hl. Messe
AUGUSTINERKLOSTER
:
09:30
: Gottesdienst
ST. SEVERI: Hl. Messe
DOM ST. MARIEN
: Gottesdienst SPORT
SONNTAG 02. JULI LAGO DI ALPI ERFURT LAGO DI ALPI - SUP RACE
INFO@AQUA-FUN.COM – AQUA-FUN AM ALPERSTEDTER SEE - ERFURT

VORSCHAU-TIPP:
MEUTE
15.7.2023, 20 Uhr, Festwiese Petersberg
MEUTE ist eine Techno Marching Band –elf Schlagzeuger und Bläser aus Hamburg, die mit ihren akustischen Instrumenten den Job eines DJs erfüllen.

Das archaische Konglomerat aus Bläsern und Schlagzeug kreiert ein neues Genre, indem es hypnotisch treibenden Techno mit ausdrucksstarker Blasmusik verbindet.
Meute löst die elektronische Musik vom DJ-Pult und entfaltet den Energieschub auf der Bühne oder direkt in der Crowd.
Ob auf der Straße oder im Club, mit oder ohne Strom – MEUTE läuft!
Tickets: (0361) 66 40 100
KULTUR
10:00 THEATER WAIDSPEICHER, PUPPENTHEATER: Der standhafte Zinnsoldat, ab 6 J.

12:00 KAUFMANNSKIRCHE: 20 Min. Orgelmusik
16:20
18:50
19:30
KINOKLUB: 20.000 Arten von Bienen (ES, 23)
KINOKLUB: Vamos A la Playa (DE/CU, 2022)
KABARETT DIE ARCHE: Von der Pampelmuse geküsst – Der Heinz-Erhardt-Abend h
20:50 KINOKLUB: 3.–5.7., 20.50: Bis ans Ende der Nacht (DE, 2023)
KIRCHE
18:00 DOM ST. MARIEN: Abendmesse
20:00 AUGUSTINERKLOSTER: Offener Meditationsabend im Waidhaus
FREIZEIT
06:30 DOMPLATZ: Frischwarenmarkt
08:30
10:00
11/15
11/14
11:00
11/14
12:15
MYTAOGARDEN AKADEMIE: Auszeit für Sie-Ein Geschenk an die Frau
MAISLABYRINTH: Biergarten&BrezelTag
BESUCHERZENTRUM ZITADELLE
PETERSBERG: Geheimnisvolle Wege durch die barocke Stadtfestung
ERFURT TOURIST INFO: Altstadtführung
KAUFMANNSKIRCHE: Die Kaufmannskirche –ein verborgener Schatz
SONDERHALTESTELLE DOMPLATZ SÜD: Erfurt-Tour: Fahrt mit der hist. Straßenbahn
ELISABETHKAPELLE IM NIKOLAITURM: Führung in der Elisabethkapelle
14:00 DOM ST. MARIEN: Domführung
17:00
17:30
APFELGUT ERFURT: Lavendel & Rosen
BESUCHERZENTRUM ZITADELLE
Erfurt – die Faszination einer historischen Stadt erleben

Es erwartet Sie ein interessanter Spaziergang durch die Altstadt (ohne Innenbesichtigungen).
Täglich um 11 und 14 Uhr, zusätzlich Fr/Sa 16 Uhr.
19:00
PETERSBERG: Funzelführung mit Taschenlampen in den Horchgängen
AUGUSTINERKIRCHE: Geistige und leibliche Genüsse
REGION
10:00
WEIMAR/DNT, STUDIO: Concerto Flautino
18 JuliTERMINE MO 3.
Foto: Wozniak
KULTUR
16:20 KINOKLUB: 20.000 Arten von Bienen (ES, 23)
17:00 ANDREASKIRCHE: 20 Minuten Orgelmusik
18:00 BARFÜSSERKIRCHE: Teatra Pak
18:50 KINOKLUB: Vamos A la Playa (DE/CU, 2022)
19:00 OFFENE ARBEIT: Konzert mit der KlezmerJam-Kapelle
19:30 HAUS DACHERÖDEN: SWE SPECIAL –Marlen Hobrack: Klassenbeste m

19:30 KABARETT DIE ARCHE: Geht's noch?! –Best of BUB
20:50 KINOKLUB: 3.–5.7., 20.50: Bis ans Ende der Nacht (DE, 2023)
KIRCHE
18:00 DOM ST. MARIEN: Abendmesse
18:00 ELISABETHKAPELLE IM NIKOLAITURM: Abendandacht
SPORT
17:30 EGAPARK: Bodybalance mit der AOK Plus

FREIZEIT
06:30 DOMPLATZ: Frischwarenmarkt
10:00 MAISLABYRINTH ERFURT: Sport & SpieleTag – Tischtennis / Kicker / Darts



10:00 NATURKUNDEMUSEUM: Schlaumeierquiz
11:00 BESUCHERZENTRUM ZITADELLE
PETERSBERG: Geheimnisvolle Wege durch die barocke Stadtfestung
11/14 ERFURT TOURIST INFORMATION: Altstadtführung Erfurt – Die Faszination einer historischen Stadt erleben
11/14 SONDERHALTESTELLE DOMPLATZ SÜD: Erfurt-Tour: Fahrt mit der historischen Straßenbahn
14:00 DOM ST. MARIEN: Domführung
15:00 BESUCHERZENTRUM ZITADELLE
PETERSBERG: Geheimnisvolle Wege durch die barocke Stadtfestung
16:00 VOLKSKUNDEMUSEUM: Führung durch die Sonderausstellung „SCHWEINsKRAM: Künstlerisches, Rares, Albernes, Museales aus der Privatsammlung Eberhard Frank“
17:00 MYTAOGARDEN AKADEMIE: Vortrag: Reduziere all deine Ausgaben um 20 Prozent, wie wäre das?
17:30 BESUCHERZENTRUM ZITADELLE
PETERSBERG: Funzelführung mit Taschenlampen in den Horchgängen der Zitadelle Petersberg
REGION
10:00 WEIMAR/DNT, STUDIO: Kuckuck im Koffer
19:00 WEIMAR/E-WERK: Der Diener zweier Herren

JuliTERMINE DI 4.
Reservierungen unter: 0361 / 373 52 52 Gasthof Schloss Hubertus • Arnstädter Chaussee 9 • 99096 Erfurt www.gasthof-schloss-hubertus.de
Brunch Immer sonntags von 10 - 14 Uhr 24,90 € pro Person gemütlich und lecker
SONNTAGS
Foto: Michael Bader
TERMINE MI 5.
KULTUR
10:00 THEATER WAIDSPEICHER, PUPPENTHEATER: Der standhafte Zinnsoldat, ab 6 J.
12:00 KUNSTHALLE ERFURT: Kunstpause
13:00 ANGERMUSEUM: Kunstpause
16:20 KINOKLUB: 20.000 Arten von Bienen (ES, 23)
18:50 KINOKLUB: Vamos A la Playa (DE/CU, 2022)
19:00 BARFÜSSERKIRCHE: Unichor Erfurt
19:30 BARFÜSSERKIRCHE: Erfurt in Licht und Schatten (Tel. 0361/66 40 100)
FAUSTS VERDAMMNIS
LA DAMNATION DE FAUST
30. DomStufen-Festspiele in Erfurt
7.7. bis 30.7.2023, Domplatz
Erleben Sie Hector Berlioz' Oper vor der historischen Kulisse aus Dom und Severikirche und lassen Sie sich begeistern, wenn das Theater Erfurt die 70-stufige Freitreppe wieder in eine der schönsten Festivalbühnen der Welt verwandelt.
Das grandios aufspielende Philharmonische Orchester Erfurt, großartige internationale Solisten und ein Chor mit über 65 Personen schaffen eine ganz besondere Atmosphäre inmitten der Erfurter Altstadt.
Freuen Sie sich auf einen tollen Abend mit schöner Musik und stimmungsvollen Bilder, an dem der Dom selbst zum Mitspieler wird.
VERLOSUNG: 2 x 2 Freikarten für „FAUSTS VERDAMMNIS“ (30.7.2023, 20.30 Uhr)
verlost:ERFURT
Teilnahme: Nur am 5.7., 10 – 18 Uhr in der Erfurt Tourist Information oder unter www.erfurt-magazin.info
Kunsthandlung Valdeig

Aquarellkalender, Kunstkarten, Bilder und Grafik von Alt-Erfurt, Geschenke, Accessoires
Kettenstr. 10, 99084 Erfurt
Tel. (0361) 5506730
www.valdeig-fineart.de
19:30 KAUFMANNSKIRCHE: Chorkonzert des Liederkreis e. V. „Sommerwind“
20:00 PREDIGERKIRCHE: Orgelkonzert
20:50 KINOKLUB: 3.–5.7., 20.50: Bis ans Ende der Nacht (DE, 2023)
21:00 ANGERMUSEUM: Der Glöckner von Notre Dame (Tel. 0361/66 40 100)
KIRCHE
18:00 AUGUSTINERKIRCHE: Taizé-Andacht
18:00 DOM ST. MARIEN: Abendmesse
SPORT
17:00 SÜDPARK: Sport im Park
FREIZEIT
06:30 DOMPLATZ: Frisch- und Hartwarenmarkt
10:00 NATURKUNDEMUSEUM: Schlaumeierquiz
11/15 BESUCHERZENTRUM ZITADELLE
PETERSBERG: Geheimnisvolle Wege...
11/14 ERFURT TOURIST INFO: Altstadtführung
11/14 SONDERHALTESTELLE DOMPLATZ SÜD: Erfurt-Tour: Fahrt mit der hist. Straßenbahn
14:00 DOM ST. MARIEN: Domführung
14:30 DOMPLATZ: Kulinarische Stadtführung
„Erfurt macht blau“ (Tel. 0361 /66 40 100)




15:00 DOMSCHATZKAMMER: Führung
17:30 BESUCHERZENTRUM ZITADELLE
18:00
PETERSBERG: Funzelführung
MAISLABYRINTH: Lagerfeuer & Stockbrot
23:00 ENGELSBURG: FH Sommerfest – Aftershow
REGION
10:00
WEIMAR/THEATER MOBIL: Kuckuck im Koffer – mobil
18:00 RUDOLSTADT/THEATER: Herscht 07769
19:00
19:00
WEIMAR/DNT, STUDIO: Schnee
WEIMAR/E-WERK: Der Diener zweier Herren
20 Juli
im Stadtplan B3
Foto: Lutz Edelhoff
magazin
KULTUR
10:00 THEATER WAIDSPEICHER, PUPPENTHEATER: Daumesdick, ab 4 J.
16:40 KINOKLUB: Alma & Oskar (DE/AT/CH/CZ, 2021)
18:30 KINOKLUB: Mein fabelhaftes Verbrechen
19:30
AUGUSTINERKLOSTER: Goldstaub –Geschichten die das Herz erfreuen (Tel. 0361/66 40 100)
19:30 HAUS DACHERÖDEN: Open Air Sommernachtskino: Namaste Himalaya
20:00 BARFÜSSERKIRCHE: Faroul
20:30 KINOKLUB: The Whale (OmU, USA, 2022)
21:00 ANGERMUSEUM: Der Glöckner von Notre Dame (Tel. 0361/66 40 100)
KIRCHE
14:00 KAUFMANNSKIRCHE: Öffentliche Führung
18:00 AUGUSTINERKIRCHE: Abendgebet / engl.
18:00 DOM ST. MARIEN: Abendmesse
SPORT
17:30
EGAPARK ERFURT: Yoga mit der AOK Plus
FREIZEIT
06:30 DOMPLATZ: Frischwarenmarkt
08:30 MYTAOGARDEN AKADEMIE: Aufbaukurs
FengShui 3/4
09:00 DOM ST. MARIEN: Turm- und Glockenführung, stündlich bis 13:00
10:00 NATURKUNDEMUSEUM: Schlaumeierquiz
10:30
SONDERHALTESTELLE DOMPLATZ SÜD: Altstadt-Express, stündlich bis 15:30
11/15 BESUCHERZENTRUM ZITADELLE
PETERSBERG: Geheimnisvolle Wege...
11/14 ERFURT TOURIST INFO: Altstadtführung
11/14 SONDERHALTESTELLE DOMPLATZ SÜD: Erfurt-Tour: Fahrt mit der hist. Straßenbahn
14:00 DOM ST. MARIEN: Domführung
14:00 DOMPLATZ: Kulinarische Stadtführung
„Andreasviertel-Tour“ (Tel. 0361 /66 40 100)
14:00 WENIGEMARKT: Kulinarische Stadtführung
„Altstadt-Tour“ (Tel. 0361 /66 40 100)
17:30 BESUCHERZENTRUM ZITADELLE
PETERSBERG: Funzelführung
18:00 CAPONNIERE RESTAURANT IM EGAPARK: Weinwochen „Grillen & Wein“
18:00
JuliTERMINE
KINO-TIPPS:
6. bis 12. Juli 2023 im Kinoklub am Hirschlachufer
6.–9.7., 16.40 / 10.–12.7., 19.00: Alma & Oskar (DE/AT/CH/CZ, 2021) Als der Komponist Gustav Mahler (Marcello De Nardo) 1912 stirbt, muss sich seine Frau Alma (Emily Cox) um materielle Belange keine Sorgen mehr machen. Doch Alma ist all das zuwider. Auch genau deshalb lässt sie sich auf eine Affäre mit dem expressionistischen Maler Oskar Kokoschka (Valentin Postlmayr) ein. Die heraufziehenden Konflikte sind praktisch programmiert.
6.–9.7., 18.30 / 10.–12.7., 20.50: Mein fabelhaftes Verbrechen (FR, 2023) Madeleine Verdier (Nadia Tereszkiewicz), eine junge, hübsche, mittellose und leider auch ziemlich untalentierte Schauspielerin, wird des Mordes an einem berühmten Produzenten beschuldigt. Mit Hilfe ihrer besten Freundin Pauline (Rebecca Marder), einer arbeitslosen Anwältin, kann sie sich jedoch noch einmal aus der scheinbar aussichtslosen Situation herauswinden. i

6.–9.7., 20.30 (OmU) / 10.–12.7., 16.30: The Whale (USA, 2022) Charlie (Brendan Fraser) hat vor vielen Jahren seine einstige Familie verlassen, um mit einem Mann zusammen sein zu können. Nachdem dieser stirbt, fällt Charlie in ein seelisches Tief. Aufgrund der schweren Trauer entwickelte der inzwischen mehr als 270 Kilo schwere Charlie eine Essstörung und hat Probleme, den Alltag zu bewältigen. Als seine Vergangenheit ihn immer mehr einholt, beschließt er, sich mit seiner 17-jährigen Tochter Ellie (Sadie Sink) wieder in Verbindung zu setzen.
MAISLABYRINTH ERFURT: Lagerfeuer & Stockbrot ab Sonnenuntergang + Biergarten
19:00 HAUS DACHERÖDEN: Zeichenkurs
19:00 STADTMUSEUM: Eröffnung der Sonderausstellung „Erfurt Entfesselt“
19:00 VHS: Stammtisch Philosophie – Oswald Spenglers „Der Mensch und die Technik“
20:00 ERFURT TOURIST INFORMATION: Romantischer Abendspaziergang…
20:00 KALIF STORCH: Tischtennis – Elektro House
19:00 WEIMAR/E-WERK: Der Diener zweier Herren
21
DO 6.
REGION
Minimal
VORSCHAU-TIPPS:
ROLAND KAISER
18.8.2023, 20 Uhr, Domplatz
Roland Kaiser schafft es nach wie vor mühelos, seinem Publikum außergewöhnliche, hoch emotionale und unvergessliche Live-Abende zu bereiten – etwas, was dem deutschen StarGiganten unter den Künstlern sehr am Herzen liegt und in dieser Zeit vielleicht noch wichtiger ist als je zuvor. Für seine Fans gilt im Sommer: KAISERMANIA in ganz Deutschland!
BROILERS

19.8.2023, 19 Uhr, Domplatz
Die Broilers kommen mit „Niemand wird zurückgelassen! – Sommer 2023“ zurück. „Wir haben einen Konzert-Sommer hinter uns, der sich gewaschen hat! Broilers waren, sind und bleiben eine Live-Band! Wir haben Bock, für Euch wieder auf die Bühne zu steigen –Es gibt noch zu viele Buden abzureißen, da sind noch Städte, die besucht werden wollen.“
Tickets: (0361) 66 40 100
KULTUR
10:00 THEATER WAIDSPEICHER, PUPPENTHEATER: Daumesdick, ab 4 J.
16:30 ANKERPLATZ: Picknick Konzert

16:40 KINOKLUB: Alma & Oskar (DE/AT/CH/CZ, 2021)
18:30
KINOKLUB: Mein fabelhaftes Verbrechen (FR, 2023)
19:00 GALLI THEATER: MännerschlussverkaufDie Kultkomödie
19:30 AUGUSTINERKLOSTER: GoldstaubGeschichten die das Herz erfreuen (Tel. 0361/66 40 100)
19:30
BARFÜSSERKIRCHE: Erfurt in Licht und Schatten (Tel. 0361/66 40 100)
19:30 HAUS DACHERÖDEN: SWE SPECIALMarco Kirchhof und Petra Schwarz i

20:00
BARFÜSSERKIRCHE: Barfüßer Open Air 2023 | Odd Diversity 5.0: Ungleich Magazin
20:30 DOMPLATZ: PREMIERE: DomStufenFestspiele 2023: Fausts VerdammnisOper von Hector Berlioz h

20:30 KINOKLUB: The Whale (OmU, USA, 2022)
20:30
21:00
21:00
22:00
23:00
NATURKUNDEMUSEUM: Der kleine PrinzUnterwegs zu den Sternen (Tel. 66 40 120)
ANGERMUSEUM: Der Glöckner von Notre Dame (Tel. 0361/66 40 100)
KABARETT DIE ARCHE: Mann mit Grill sucht Frau mit Kohle
KULTURHOF KRÖNBACKEN: Open Air im Krönbacken: Fucking Bornholm (PL, 2022)
ENGELSBURG: Last Resort
22 JuliTERMINE FR
7.
Foto: Steffen Schmid
Foto: Robert Eikelpoth
Foto: Lutz Edelhoff
Foto: Urbschat Kleinmachnow
12:00 AUGUSTINERKLOSTER: Friedensgebet
18:00 DOM ST. MARIEN: Abendmesse
FREIZEIT
06:30 DOMPLATZ: Frisch- und Hartwarenmarkt
08:30 MYTAOGARDEN AKADEMIE: Aufbaukurs
FengShui 3/4
10:00 NATURKUNDEMUSEUM: Schlaumeierquiz

10:30
11/15
SONDERHALTESTELLE DOMPLATZ SÜD: Altstadt-Express, stündlich bis 15:30
BESUCHERZENTRUM ZITADELLE
PETERSBERG: Geheimnisvolle Wege durch die barocke Stadtfestung
11/14 ERFURT TOURIST INFORMATION: Altstadtführung
11/14/16
SONDERHALTESTELLE DOMPLATZ SÜD: Erfurt-Tour: Fahrt mit der historischen Straßenbahn
12/14/15 DOM ST. MARIEN: Turm- und Glockenführung
13:00 DOM ST. MARIEN: Führungen zum Marienmosaik
14:00 DOM ST. MARIEN: Domführung
14:30 DOMPLATZ: Kulinarische Stadtführung
„Andreasviertel-Tour“ (Tel. 0361 /66 40 100)
14:30 WENIGEMARKT: Kulinarische Stadtführung „Altstadt-Tour“ (Tel. 0361 /66 40 100)
16:00 HAUS DACHERÖDEN: Gästeführung
„GESTERN – HEUTE – MORGEN“
17:30 BESUCHERZENTRUM ZITADELLE
PETERSBERG: Funzelführung mit Taschenlampen in den Horchgängen
18:00 CAPONNIERE RESTAURANT IM EGAPARK: Weinwochen „Grillen & Wein“
18:00 MAISLABYRINTH ERFURT: DJ LOUNGE Chillige Musik im Grünen
18:00 ZITADELLE PETERSBERG: Rundgang mit dem Petersberger Schwarzbrenner (Tel: 66 40 100)
20:00 DESTILLE, BASTION MARTIN: Vom Bauernschnaps zum Edeldestillat
20:00 ERFURT TOURIST INFORMATION: Romantischer Abendspaziergang…
21:00 AUGUSTINERKLOSTER: Luthers schlaflose Nächte in Erfurt (Tel. 0361/66 40 120)
REGION

10:00 WEIMAR/DNT, STUDIO: Die Königin der Farben
10:00 WEIMAR/THEATER MOBIL: Kuckuck im Koffer – mobil
25.Juni BIS
15.Oktober 2023
23 TERMINE FR Juli 7.
KIRCHE
P P R OL N D D D DEL L L S TR E E E U U U U L O Schloss museum Molsdorf Ina Hattenhauer Bilder für Klein und Groß
KULTUR
10:00
STEIGERWALDSTADION: WBG Zukunft
KindergartenCup 2023
11:00 FESTUNGSBÄCKEREI: Der Froschkönig
16:00 LAGUNE ERFURT: Der Prinz und die Erbse
16:40 KINOKLUB: Alma & Oskar (DE/AT/CH/CZ, 21)
18:00 THEATER/THEATRIUM: Sommerkonzerte im Theatrium: Holger-Arndt-Connexion
18:30 KINOKLUB: Mein fabelhaftes Verbrechen (FR, 2023)
19:00 ANDREASKAVALIER: JustBrill –Musikgeschichte unplugged
19:00 DOM ST. MARIEN: Orgelkonzert
19:00 GALLI THEATER: Männerschlussverkauf –Die Kultkomödie
19:30
19:30
AUGUSTINERKLOSTER: Goldstaub –Geschichten die das Herz erfreuen (Tel. 0361/66 40 100)
BARFÜSSERKIRCHE: Erfurt in Licht und Schatten (Tel. 0361/66 40 100)
19:30 KABARETT PUFFBOHNE: Salon Figaro
20:00 BARFÜSSERKIRCHE: Crazys Bigband
20:00 HEILIGEN MÜHLE: 9. Blues Rock Nacht: Thirdstonefree (Hendrix) & Mark Taylor & Friends (Blues Klassiker)
20:30 DOMPLATZ: DomStufen-Festspiele: Fausts
20:30
20:30
Verdammnis – Oper von Hector Berlioz
KINOKLUB: The Whale (OmU, USA, 2022)
NATURKUNDEMUSEUM: Der kleine Prinz –Unterwegs zu den Sternen (Tel. 66 40 120)
21:00 ANGERMUSEUM: Der Glöckner von Notre Dame (Tel. 0361/66 40 100)
21:00 KABARETT DIE ARCHE: Liebe, Lust & Trallala
21:30 EGAPARK ERFURT: Sommerkino: Ein Mann
Namens Otto
22:00 KULTURHOF KRÖNBACKEN: Open Air
Kino: Was man von hier aus sehen kann
23:00 ENGELSBURG: All you can dance
18:00 AUGUSTINERKIRCHE: Abendgebet
18:00 DOM ST. MARIEN: Vesper
18:00 KAUFMANNSKIRCHE: Abendsegen und Orgelmusik
FREIZEIT
06:30 DOMPLATZ: Frisch- und Hartwarenmarkt
10:00 MAISLABYRINTH ERFURT: Familien Tag + Kinderschminken
10:00 MUSIK-ATELIER GABEL: Workshop Blechbläser
10:00 NATURKUNDEMUSEUM: Schlaumeierquiz
10:00 ZOOPARK: Kinder- & Hüpfburgenfest f

10:15 ALTE SYNAGOGE: Öffentliche Führung
10:30
SONDERHALTESTELLE DOMPLATZ SÜD: Altstadt-Express, stündlich bis 15:30
11:00 AUGUSTINERKLOSTER: Lebenslust und Seelenqualen – Luther in Erfurt (Tel. 0361/66 40 120)
11/15 BESUCHERZENTRUM ZITADELLE
PETERSBERG: Geheimnisvolle Wege
11:00 DOM ST. MARIEN: Turm- und Glockenführung im Dom St. Marien, stündlich bis 16:00
11/14 ERFURT TOURIST INFO: Altstadtführung
11/14/16 SONDERHALTESTELLE DOMPLATZ SÜD: Erfurt-Tour: Fahrt mit der hist. Straßenbahn
11:45 MIKWE: Öffentliche Führung
13:00 DOM ST. MARIEN: Führungen Marienmosaik
13/14 DOMPLATZ: Kulinarische Stadtführung
„Andreasviertel-Tour“ (Tel. 0361 /66 40 100)
13:30 WENIGEMARKT: Kulinarische Stadtführung
„Altstadt-Tour“ (Tel. 66 40 100), auch 14:30
14:00 DOM ST. MARIEN: Domführung
14:00 STADTFARM AM KONTOR: Bau Deinen eigenen Tee an
14:30 DOMPLATZ: Kulinarische Stadtführung
„Erfurt macht blau“ (Tel. 0361 /66 40 100)
15:00 DOMSCHATZKAMMER: Führung in der neuen Domschatzkammer
15:00 VINARIUM: Rundgang durch die Aroma-Arena
16:00 ERFURT TOURIST INFO: Kurzführung
17:00 DESTILLE: Brennereiführung mit Verkostung
17:30
BESUCHERZENTRUM ZITADELLE
PETERSBERG: Funzelführung
18:00 ZUGHAFEN: Olymbierde
20:00 ERFURT TOURIST INFORMATION: Romantischer Abendspaziergang…
21:00 FLUGHAFEN: FlughafenAbendTour
22:00 CLUB PALAIS: Back to the 80s
REGION
10:30
WASSERBURG KAPELLENDORF: Open Air: Der Prinz und die Erbse
19:00 WEIMAR/DNT, STUDIO: Schnee
19:00
20:00
WEIMAR/E-WERK: Der Diener zweier Herren
SAALFELD/HOHER SCHWARM: Open Air: Klangzauber unterm Sternenzelt
24 Juli
TERMINE SA 8. KIRCHE
KULTUR

11:00 STADTGARTEN: Open Air: Dornröschen
11:00 THEATER WAIDSPEICHER, PUPPENTHEATER: Der Maulwurf und die Sterne, ab 3 J.



16:00 BARFÜSSERKIRCHE: Barfüßer Open Air 2023 | Theater im Palais: Der Prinz und die Erbse
16:40 KINOKLUB: Alma & Oskar (DE/AT/CH/CZ, 2021)
17:00 KAUFMANNSKIRCHE: Chorkonzert des Liederkreis e. V. „Sommerwind“
18:30 KINOKLUB: Mein fabelhaftes Verbrechen
20:00 BARFÜSSERKIRCHE: Klarke
20:30 DOMPLATZ: DomStufen-Festspiele: Fausts Verdammnis - Oper von Hector Berlioz
20:30 KINOKLUB: The Whale (OmU, USA, 2022) KIRCHE


08:00 CRUCISKIRCHE: Hl. Messe
09:30 AUGUSTINERKLOSTER: Gottesdienst
09:30 REGLERKIRCHE: Gottesdienst
09:30 ST. SEVERI: Hl. Messe
11/18 DOM ST. MARIEN: Gottesdienst








FREIZEIT
10:00 MAISLABYRINTH: Familientag





10:00 NATURKUNDEMUSEUM: Schlaumeierquiz
10:30
11/15
11/14
SONDERHALTESTELLE DOMPLATZ SÜD: Altstadt-Express, stündlich bis 15:30
BESUCHERZENTRUM ZITADELLE
PETERSBERG: Geheimnisvolle Wege...
ERFURT TOURIST INFO: Altstadtführung
11/14 SONDERHALTESTELLE DOMPLATZ SÜD: Erfurt-Tour: Fahrt mit der hist. Straßenbahn
11:15 KUNSTHALLE ERFURT: Führung Ausstellung „Engelberg + Inszenierte Fotografie“
13/14 DOMPLATZ: Kulinarische Stadtführung
„Historische Sonntags-Tour“ (Tel. 66 40 100)











14:00 DOM ST. MARIEN: Domführung
14/15/16 DOM ST. MARIEN: Turm- und Glockenführung im Dom St. Marien


15:00 ERINNERUNGSORT TOPF & SÖHNE: Öffentliche Führung durch die Sonderausstellung „Miriams Tagebuch –Die Geschichte der Familie Feiner“
15:00 STADTMUSEUM: Führung: „Modell Innenstadt. Planungen für die Mitte von Erfurt“
17:30
BESUCHERZENTRUM ZITADELLE
PETERSBERG: Funzelführung
18:00 EGAPARK ERFURT: Weinspaziergang –Garten & Lyrik & Wein

REGION
18:00 WEIMAR/DNT, GR. HAUS: I Capuleti e i Montecchi – Romeo und Julia
















19:30
GERA/SPARKASSEN-BÜHNE IM HOFWIESENPARK: Nena – Wir gehören zusammen
25 JuliTERMINE SO 9. im Stadtplan D2
MESSEN KONZERTE EVENTS
Nachtflohmarkt
29.07.2023
Nachtflohmarkt
26.08.2023
Pyrogames – Duell der Feuerwerker
02.09.2023
Forum Berufsstart
13. + 14.09.2023
Nachtflohmarkt
23.09.2023
Die Schlagernacht des Jahres
DAS ORIGINAL
23.09.2023
30 Jahre ANTENNE THÜRINGEN
Das Konzert
30.09.2023
One Vision of Queen Queen tribute show feat. Marc Martel
05.10.2023
Adel Tawil – Spiegelbild Tour 2023
06.10.2023
Lady Fashion & Hosenscheißer Flohmarkt
07.10.2023
Die Prinzen – Jubiläumstour: 30 Jahre – 30 Hits – 30 Städte
07.10.2023
Nino de Angelo – Live mit Band
08.10.2023
Kompletten Veranstaltungsübersicht: www.messe-erfurt.de
KULTUR
12:00 KAUFMANNSKIRCHE: 20 Min. Orgelmusik
16:30 KINOKLUB: The Whale (USA, 2022)
19:00 KINOKLUB: Alma & Oskar (DE/AT/CH/CZ, 2021)
20:50 KINOKLUB: Mein fabelhaftes Verbrechen (FR, 2023)
KIRCHE
18:00 DOM ST. MARIEN: Abendmesse
20:00 AUGUSTINERKLOSTER: Offener Meditationsabend im Waidhaus
FREIZEIT
06:30 DOMPLATZ: Frischwarenmarkt
08:30 ZOOPARK: Sommerferienspiele 2023
10:00 ERFURTER INNENSTADT: Innenstadtschatzsuche h
10:00 KULTURHOF KRÖNBACKEN: Workshop „Window Color für Alle – Mein bunter Sommer“ – ab 8 Jahren
10:00 MAISLABYRINTH: Biergarten&BrezelTag
10:00 STADTMUSEUM „HAUS ZUM STOCKFISCH“: Geocaching

11/15
11/14
11:00
11/14
12:15
BESUCHERZENTRUM ZITADELLE
PETERSBERG: Geheimnisvolle Wege durch die barocke Stadtfestung
ERFURT TOURIST INFORMATION: Altstadtführung Erfurt – Die Faszination einer historischen Stadt erleben
KAUFMANNSKIRCHE: Die Kaufmannskirche – ein verborgener Schatz
SONDERHALTESTELLE DOMPLATZ SÜD: Erfurt-Tour: Fahrt mit der historischen Straßenbahn
ELISABETHKAPELLE IM NIKOLAITURM: Führung in der Elisabethkapelle
14:00 DOM ST. MARIEN: Domführung
17:30
BESUCHERZENTRUM ZITADELLE
PETERSBERG: Funzelführung mit Taschenlampen in den Horchgängen
TERMINEJuli 26 MO 10.
KULTUR
16:30 KINOKLUB: The Whale (USA, 2022)

17:00 ANDREASKIRCHE: 20 Minuten Orgelmusik
17:00 BRÜHLER GARTEN: Creme Brühlee: Kinderkonzert „Nepomuk & der Rabel erleben neue Abenteuer“ m

19:00 KINOKLUB: Alma & Oskar (DE/AT/CH/CZ, 2021)


19:30 THEATER WAIDSPEICHER, PUPPENTHEATER: Fräulein Smillas Gespür für Schnee, ab 16 J.
20:00 CRUCISKIRCHE: Orgelkonzert an der barocken Volcklandorgel
20:30 DOMPLATZ: DomStufen-Festspiele: Fausts Verdammnis – Oper von Hector Berlioz
20:50 KINOKLUB: Mein fabelhaftes Verbrechen (FR, 2023)
KIRCHE
18:00 DOM ST. MARIEN: Abendmesse
18:00 ELISABETHKAPELLE IM NIKOLAITURM: Abendandacht
SPORT
17:30 EGAPARK: Bodybalance mit der AOK Plus FREIZEIT
06:30 DOMPLATZ: Frischwarenmarkt
08:30 ZOOPARK: Sommerferienspiele 2023
10:00 ERFURTER INNENSTADT: Innenstadtschatzsuche
10:00 KULTURHOF KRÖNBACKEN: Workshop
„Window Color für Alle – Mein bunter Sommer“ – ab 8 Jahren





10:00 MAISLABYRINTH: Sport & SpieleTag –Tischtennis / Kicker / Darts



10:00 NATURKUNDEMUSEUM: Kinderführung
„Pelikan und Bienenfresser. Von großen und kleinen Spezialisten der Vogelwelt“
10:00 NATURKUNDEMUSEUM: Schlaumeierquiz
10:00 STADTMUSEUM: Kistengrabung
11/15 BESUCHERZENTRUM ZITADELLE PETERSBERG: Geheimnisvolle Wege durch die barocke Stadtfestung
11/14 ERFURT TOURIST INFORMATION: Altstadtführung Erfurt – Die Faszination einer historischen Stadt erleben
11/14 SONDERHALTESTELLE DOMPLATZ SÜD: Erfurt-Tour: Fahrt mit der historischen Straßenbahn
12:00 STADTMUSEUM: Mittagspause in der Dauerausstellung des Stadtmuseums
14:00 DOM ST. MARIEN: Domführung
17:30 BESUCHERZENTRUM ZITADELLE
PETERSBERG: Funzelführung mit Taschenlampen in den Horchgängen der Zitadelle Petersberg SUMMERTIME
TERMINEJuli
DI 11.
12.7. ◆ 2.8. ◆ 23.8. ◆ 6.9. AB 17 UHR EINTRITT FREI BEACHPARTY IM KRESSEPARK Grill
Mandala Beachclub - Kressepark Erfurt - Motzstraße 8 • MUSIC • DRINKS • BBQ • Euch erwartet ein besonderer Grillabend, genießt tolle Grillgerichte zu guter Musik und leckeren Drinks.
& Chill
KULTUR
10:00
THEATER WAIDSPEICHER, PUPPENTHEATER: Rumpelstilzchen, ab 4 J.
12:00 KUNSTHALLE ERFURT: Kunstpause
13:00 ANGERMUSEUM: Kunstpause
16:00 BARFÜSSERKIRCHE: Kaosclown
16:00 HAUS DACHERÖDEN: Bilderbuchkino: „Die Wiesenfreunde“ g

16:30
KINOKLUB: The Whale (USA, 2022)
17:00 VINARIUM: Musik & Wein
19:00 KINOKLUB: Alma & Oskar (DE/AT/CH/CZ, 21)
19:30
ALTE OPER: Chris de Burgh i

19:30 BARFÜSSERKIRCHE: Erfurt in Licht und Schatten (Tel. 0361/66 40 100)
19:30 HAUS DACHERÖDEN: Buchbingo
20:00 BARFÜSSERKIRCHE: Barfüßer Open Air
2023 | Varieté der Wunder: Magic Comedy Artistic Show
KONZERT-TIPP:
20:00 ENGELSBURG: Queens & Kings of Karaoke
20:00 PREDIGERKIRCHE: Orgelkonzert
20:30 DOMPLATZ: DomStufen-Festspiele: Fausts Verdammnis – Oper von Hector Berlioz
20:50 KINOKLUB: Mein fabelhaftes Verbrechen
21:00
ANGERMUSEUM: Der Glöckner von Notre Dame (Tel. 0361/66 40 100)
KIRCHE
18:00 DOM ST. MARIEN: Abendmesse
SPORT
17:00 SÜDPARK: Sport im Park
FREIZEIT
06:30 DOMPLATZ: Frisch- und Hartwarenmarkt
08:30 MYTAOGARDEN AKADEMIE: Jährliche Pflichtfortbildung für Betreuungskräfte –Jahresauffrischungskurs
08:30 ZOOPARK: Sommerferienspiele 2023
10:00 ERFURTER INNENSTADT: Innenstadtschatzsuche
10:00 FLUGHAFEN: FlughafenFerienTour
10:00
10:00
CHRIS DE BURGH
12.7.2023, 19.30 Uhr, Alte Oper
In eine neue Tour-Runde gehen die Solo-Shows, die Chris de Burgh seit 2004 immer wieder spielt. Von diesen intimen Konzerten des beliebten Singer/Songwriters sind Besucher und Kritiker stets gleichermaßen begeistert. Bei seinen Solo-Konzerten spielt Chris de Burgh alte und neue Songs aus seiner Feder so, wie er sie einst komponiert hat: pur und auf das Wesentliche reduziert. Ein authentischer Künstler, der nahbar ist, und Musik sind hier Trumpf!
Tickets: (0361) 66 40 100
KULTURHOF KRÖNBACKEN: Workshop
„Window Color für Alle – Mein bunter Sommer“ – ab 8 Jahren
NATURKUNDEMUSEUM: Schlaumeierquiz
11/15 BESUCHERZENTRUM ZITADELLE
11/14
11/14
PETERSBERG: Geheimnisvolle Wege...
ERFURT TOURIST INFO: Altstadtführung
SONDERHALTESTELLE DOMPLATZ SÜD: Erfurt-Tour: Fahrt mit der hist. Straßenbahn
14:00 DOM ST. MARIEN: Domführung
14:30
15:00
17:30
18:00
DOMPLATZ: Kulinarische Stadtführung
„Erfurt macht blau“ (Tel. 0361 /66 40 100)
DOMSCHATZKAMMER: Führung
BESUCHERZENTRUM ZITADELLE
PETERSBERG: Funzelführung
MAISLABYRINTH ERFURT: Lagerfeuer & Stockbrot ab Sonnenuntergang + Biergarten
REGION
16:00
19:00
19:30
GROSSSCHWABHAUSEN/KIRMESPLATZ: Open Air: Der Froschkönig
WEIMAR/E-WERK: Der Diener zweier Herren
RUDOLSTADT/HEIDECKSBURG: Open Air: MMM – Was bin ich?
28 JuliTERMINE MI 12.
Foto: KBK GmbH
KULTUR
10:00
THEATER WAIDSPEICHER, PUPPENTHEATER: Rumpelstilzchen, ab 4 J.
16:30 KINOKLUB: Living – Einmal wirklich leben (GB, 2022)

18:40
19:00
19:30
20:00
KINOKLUB: The Art of Love (GB/CH, 2022)
MAISLABYRINTH: in Concert: simple live
BARFÜSSERKIRCHE: Erfurt in Licht und Schatten (Tel. 0361/66 40 100)
BARFÜSSERKIRCHE: Josepha Wawaa & Sijeb + Gesa: Neo Soul / Funk / Hip Hop / Blues
20:30 DOMPLATZ: DomStufen-Festspiele: Fausts Verdammnis – Oper von Hector Berlioz
20:50 KINOKLUB: Mein fabelhaftes Verbrechen (FR, 2023)
21:00 ANGERMUSEUM: Der Glöckner von Notre Dame (Tel. 0361/66 40 100)
KIRCHE
18:00 AUGUSTINERKIRCHE: Abendgebet / engl.
18:00 DOM ST. MARIEN: Abendmesse
SPORT
17:30 EGAPARK ERFURT: Yoga mit der AOK Plus FREIZEIT
06:30 DOMPLATZ: Frischwarenmarkt
08:30 MYTAOGARDEN AKADEMIE: Jährliche Pflichtfortbildung für BetreuungskräfteJahresauffrischungskurs
08:30 ZOOPARK: Sommerferienspiele 2023
09:00 DOM ST. MARIEN: Glockenführung, stündlich bis 13 Uhr
10:00 ERFURTER INNENSTADT: Innenstadtschatzsuche
10:00 KULTURHOF KRÖNBACKEN: Workshop
„Window Color für Alle – Mein bunter Sommer“ – ab 8 Jahren
10:00 NATURKUNDEMUSEUM: Kinderführung
„Kleine Reise zu den Tieren unserer Erde“
10:00 NATURKUNDEMUSEUM: Schlaumeierquiz
10:00 STADTMUSEUM: Gewappnet
10:30
KINO-TIPPS:
13. bis 19. Juli 2023 im Kinoklub am Hirschlachufer
13.–16.7., 16.30 / 17.–19.7., 18.40: Living – Einmal wirklich leben (GB, 2022) Großbritannien, 1953: Williams (Bill Nighy), ein hochrangiger Beamter des London County Council, ist ein ohnmächtiges Rädchen in der bürokratischen Stadt, die um den Wiederaufbau kämpft. Mit dem Erhalt einer erschütternden medizinischen Diagnose ändert sich plötzlich sein gesamtes Leben. Als er auf den fremden Mr. Sutherland (Tom Burke) trifft, kommt plötzlich jedoch alles anders. i
13.–16.7., 18.40 / 17.–19.7., 20.40: The Art of Love (GB/CH, 2022) Die Bahnangestellte Eva (Alexandra Gilbreath), Mitte 50, ist von ihrem Leben gelangweilt und in ihrer Ehe läuft es alles andere als prickelnd. Um ihre Beziehung wieder aufleben zu lassen, schreibt sie heimlich Sextoy-Bewertungen. Als sie nun für ein neues Projekt bei dem Start-Up „The Art Of Love“ mit dem 35 Jahre alten Influencer Adam (Oliver Walker) zusammenarbeiten soll, stellt sich bei ihr nicht gerade Begeisterung ein.
17.–19.7., 16.40: Das Lehrerzimmer (DE, 2023) Carla (Leonie Benesch) ist Mathematik- und Sportlehrerin und nicht nur neu an ihrer Schule, sondern überhaupt im Beruf. Kaum angekommen, stellt sie fest, dass dort gestohlen wird. Nun könnte sie sich mit diesem Zustand abfinden, aber genau das will sie eben nicht tun. Getrieben von ihrem noch ungebrochenen Idealismus beginnt sie zu ermitteln und stößt dabei insbesondere bei ihrem Kollegium, den Eltern und ihren Schülern auf Unverständnis.
SONDERHALTESTELLE DOMPLATZ SÜD: Altstadt-Express, stündlich bis 15:30
11/15 BESUCHERZENTRUM ZITADELLE
PETERSBERG: Geheimnisvolle Wege...
11/14 ERFURT TOURIST INFO: Altstadtführung
11/14
SONDERHALTESTELLE DOMPLATZ SÜD: Erfurt-Tour: Fahrt mit der hist. Straßenbahn
14:00 DOM ST. MARIEN: Domführung
14:00 DOMPLATZ: Kulinarische Stadtführung
„Andreasviertel-Tour“ (Tel. 0361 /66 40 100)
14:00 WENIGEMARKT: Kulinarische Stadtführung
„Altstadt-Tour“ (Tel. 0361 /66 40 100)
17:30 BESUCHERZENTRUM ZITADELLE
PETERSBERG: Funzelführung
18:00 CAPONNIERE RESTAURANT IM EGAPARK: Weinwochen „Grillen & Wein“
20:00 ERFURT TOURIST INFORMATION: Romantischer Abendspaziergang…
29 TERMINE DO 13. Juli
VORSCHAU-TIPP:
KIRCHE
12:00 AUGUSTINERKLOSTER: Friedensgebet
18:00 DOM ST. MARIEN: Abendmesse
FREIZEIT
06:30 DOMPLATZ: Frisch- und Hartwarenmarkt
08:30
SANTIANO JUBILÄUMSTOURNEE
20.8.2023, 19 Uhr, Domplatz
Santiano gelingt es, mit ihrer Musik mühelos ein ungemein vielseitiges Publikum zu vereinen. Sie alle feiern die Musik von Santiano gleichermaßen – es wird gemeinsam gelacht, lauthals mitgesungen, getanzt und gefeiert, bis auch der allerletzte Ton verklungen ist.
Tickets: (0361) 66 40 100
KULTUR
10:00
THEATER WAIDSPEICHER, PUPPENTHEATER: Daumesdick, ab 4 J.
16:30 KINOKLUB: Living – Einmal wirklich leben (GB, 2022)
18:00
18:40
THEATER/THEATRIUM: Sommerkonzerte im Theatrium: Sommerliche Träume
KINOKLUB: The Art of Love (GB/CH, 2022)
19:00 GALLI THEATER: Männerschlussverkauf –Die Kultkomödie
19:00 PETERSBERG – FESTWIESE: Silbermond
19:00
MICHAELISKIRCHE: Hofkonzert
20:00 BARFÜSSERKIRCHE: Catt
20:30 DOMPLATZ: DomStufen-Festspiele: Fausts
20:30
Verdammnis – Oper von Hector Berlioz
NATURKUNDEMUSEUM: Der kleine Prinz –Unterwegs zu den Sternen (Tel. 66 40 120)
20:50 KINOKLUB: Mein fabelhaftes Verbrechen (FR, 2023)
21:00 ANGERMUSEUM: Der Glöckner von Notre Dame (Tel. 0361/66 40 100)
22:00 KULTURHOF KRÖNBACKEN: Open Air

Kino: Sophia, der Tod und ich (DE, 2023)
MYTAOGARDEN AKADEMIE: FengShui Species 4/4
08:30 ZOOPARK: Sommerferienspiele 2023
10:00 ERFURTER INNENSTADT: Innenstadtschatzsuche
10:00 KULTURHOF KRÖNBACKEN: Workshop
„Window Color für Alle – Mein bunter Sommer“ – ab 8 Jahren
10:00 NATURKUNDEMUSEUM: Schlaumeierquiz
10:00 VOLKSKUNDEMUSEUM: Zusammen_falten – Origami
10:30 SONDERHALTESTELLE DOMPLATZ SÜD: Altstadt-Express – Fahrt mit dem Gelenkbus, stündlich bis 15:30
11/15 BESUCHERZENTRUM ZITADELLE
PETERSBERG: Geheimnisvolle Wege durch die barocke Stadtfestung
11/14 ERFURT TOURIST INFORMATION: Altstadtführung Erfurt – Die Faszination einer historischen Stadt erleben
11/14/16 SONDERHALTESTELLE DOMPLATZ SÜD: Erfurt-Tour: Fahrt mit der his. Straßenbahn
12:00 DOM ST. MARIEN: Turm- und Glockenführung im Dom St. Marien, stündlich bis 15:00
13:00 DOM ST. MARIEN: Führungen zum Marienmosaik
14:00 DOM ST. MARIEN: Domführung
14:30 DOMPLATZ: Kulinarische Stadtführung
„Andreasviertel-Tour“ (Tel. 0361 /66 40 100)
14:30 WENIGEMARKT: Kulinarische Stadtführung
„Altstadt-Tour“ (Tel. 0361 /66 40 100)
16:00 ERFURT TOURIST INFORMATION:
Kurzführung – Historische Altstadt
17:30 BESUCHERZENTRUM ZITADELLE
PETERSBERG: Funzelführung mit Taschenlampen in den Horchgängen
17:30 LAGO DI ALPI (ALPERSTEDTER SEE): Yoga & Wine
18:00
18:00
18:00
20:00
21:00
CAPONNIERE RESTAURANT IM EGAPARK: Weinwochen „Grillen & Wein“
MAISLABYRINTH ERFURT: DJ LOUNGE
Chillige Musik im Grünen
ZITADELLE PETERSBERG: Rundgang mit dem Petersberger Schwarzbrenner (Tel: 66 40 100)
ERFURT TOURIST INFORMATION: Romantischer Abendspaziergang…
AUGUSTINERKLOSTER: Luthers schlaflose Nächte in Erfurt (Tel. 0361/66 40 120)
REGION
19:00
20:00
WEIMAR/E-WERK: Der Diener zweier Herren
RUDOLSTADT/HEIDECKSBURG: Open Air: Das Geheimnis der drei Tenöre
30 Juli
TERMINE 14. FR
Foto: Christian Barz
























www.ekhof-festival.de 16. Juni –22. September
KULTUR
11:00 DOMPLATZ: PREMIERE: DOMINO –DomStufen-Festspiele für die Kleinen 2023: Jim Knopf und Lukas der Lokomotivführer h

11:00 FESTUNGSBÄCKEREI: Open Air: Der Froschkönig
13:00 ZUGHAFEN: Blaumachen Festival 2023
15:00 EGAPARK: Geschichten unterm Lesebaum
16:30 KINOKLUB: Living – Einmal wirklich leben (GB, 2022)
18:40 KINOKLUB: The Art of Love (GB/CH, 2022)
19:00 GALLI THEATER: Männerschlussverkauf –Die Kultkomödie
19:00 JAZZCLUB ERFURT : Duo Besson – Pazdera (FR/CZ)
19:30 BARFÜSSERKIRCHE: Erfurt in Licht und Schatten (Tel. 0361/66 40 100)
19:30 CRUCISKIRCHE: Orgelkonzert an der barocken Volcklandorgel
20:00 BARFÜSSERKIRCHE: Brise Manouche
20:00 DASDIE LIVE: Travestie-Revue „Pretty Wo(man)“
20:00 PETERSBERG – FESTWIESE: Meute
20:30
20:30
DOMPLATZ: DomStufen-Festspiele: Fausts Verdammnis – Oper von Hector Berlioz
NATURKUNDEMUSEUM: Der kleine Prinz –Unterwegs zu den Sternen (Tel. 66 40 120)
20:50 KINOKLUB: Mein fabelhaftes Verbrechen (FR, 2023)
21:00 ANGERMUSEUM: Der Glöckner von Notre Dame (Tel. 0361/66 40 100)
21:00 KAUFMANNSKIRCHE: Sommernachtskonzert Brassband Schnaftl Ufftschik
22:00 CLUB CENTRAL: The Great 80ies
22:00 KULTURHOF KRÖNBACKEN: Open Air Kino: Oskars Kleid (DE, 2022)
23:00 ENGELSBURG: All you can dance
KIRCHE
18:00 AUGUSTINERKIRCHE: Abendgebet
18:00 DOM ST. MARIEN: Vesper
18:00 KAUFMANNSKIRCHE: Abendsegen und Orgelmusik
SPORT
11:00 ANGER 1: Biathlon-Deutschlandtour 2023
FREIZEIT
06:30 DOMPLATZ: Frisch- und Hartwarenmarkt
08:30 MYTAOGARDEN AKADEMIE: FengShui Species 4/4
10:00 MAISLABYRINTH ERFURT: Familientag
10:00 NATURKUNDEMUSEUM: Schlaumeierquiz
10:15 ALTE SYNAGOGE: Öffentliche Führung
10:30
SONDERHALTESTELLE DOMPLATZ SÜD: Altstadt-Express, stündlich bis 15:30
11/15 BESUCHERZENTRUM ZITADELLE PETERSBERG: Geheimnisvolle Wege...
11/12 DOM ST. MARIEN: Glockenführung
11/14 ERFURT TOURIST INFO: Altstadtführung
11:00
AUGUSTINERKLOSTER: Lebenslust und Seelenqualen – Luther in Erfurt (Tel. 0361/66 40 120)
11/14/16 SONDERHALTESTELLE DOMPLATZ SÜD: Erfurt-Tour: Fahrt mit der hist. Straßenbahn
11:45 MIKWE: Öffentliche Führung
13:00 AUGUSTINERKLOSTER: Kloster kulinarisch –Essen wie zu Luthers Zeiten (Tel. 66 40 120)
13:00 DOM ST. MARIEN: Führungen zum Marienmosaik
13/14 DOMPLATZ: Kulinarische Stadtführung
„Andreasviertel-Tour“ (Tel. 0361 /66 40 100)
13:30 WENIGEMARKT: Kulinarische Stadtführung
„Altstadt-Tour“ (Tel. 0361 /66 40 100), auch 14:30
14/15/16 DOM ST. MARIEN: Glockenführung
14:00 DOM ST. MARIEN: Domführung
14:00 EUROPAPLATZ: Wein Genuss Wanderung
Gera Aue (Tel. 0361/66 40 120)
14:30 DOMPLATZ: Kulinarische Stadtführung
„Erfurt macht blau“ (Tel. 0361 /66 40 100)
15:00 DOMSCHATZKAMMER: Führung
15:00 VINARIUM: Rundgang durch die Aroma-Arena
16:00 ERFURT TOURIST INFO: Kurzführung
17:00 DESTILLE: Brennereiführung mit Verkostung
17:30 BESUCHERZENTRUM ZITADELLE
PETERSBERG: Funzelführung mit Taschenlampen in den Horchgängen
20:00 ERFURT TOURIST INFORMATION: Romantischer Abendspaziergang…
22:00 CLUB PALAIS: Schlagerkeller
REGION
10:30 WASSERBURG KAPELLENDORF: Open Air: Hans im Glück
19:00 BURG CREUZBURG: Open Air: Candlelight & Liebestöter
19:30 RUDOLSTADT/HEIDECKSBURG: Open Air: Soundtrack des Sommers
20:00 RUDOLSTADT/HEIDECKSBURG: Open Air: Das Geheimnis der drei Tenöre
20:00 WEIMAR/WEIMARHALLENPARK: Fly Me To The Moon
32 JuliTERMINE 15. SA
Foto: Lutz Edelhoff










DOMINO – DOMSTUFEN-FESTSPIELE FÜR DIE KLEINEN 15.07. – 27.07.2023 KINDEROPER VON TOBIAS ROKAHR UND KATHARINA TARJÁN JIM KNOPF UND LUKAS DER LOKOMOTIVFÜHRER www.domstufen-festspiele.de 6+
VORSCHAU-TIPP:
KULTUR
11/14 DOMPLATZ: DOMINO – DomStufen-Festspiele für die Kleinen: Jim Knopf und Lukas der Lokomotivführer
11:00
11:00
15:00
16:30
18:40
20:30
20:50
CLUESO
26.8.2023, 18.30 Uhr (ausverkauft)
27.8.2023, 18 Uhr, Domplatz
Trotz musikalischem Neuanfang hat Clueso seiner Heimatstadt nie den Rücken gekehrt. Ganz im Gegenteil: Mit „Leider Berlin“ hat er eine echte Erfurt–Hymne rausgebracht. Fünf Jahre nach seinem letzten Open Air Heimspiel kehrte er 2022 an den schönsten Ort der Stadt zurück und gab ein Konzert auf dem Domplatz. Loslassen und festhalten, Gas geben und innehalten – die Konzerte von Clueso in Erfurt sind etwas Besonderes.
Tickets: (0361) 66 40 100
10:00
10:30
: Open Air: Dornröschen
WAIDSPEICHER: Daumesdick, ab 4
: Konzert des Kammermusikverein e. V.
11/14
11/14
TOURIST INFO: Altstadtführung
DOMPLATZ SÜD: Erfurt-Tour: Fahrt mit der hist. Straßenbahn
13/14 DOMPLATZ: Kulinarische Stadtführung
„Historische Sonntags-Tour“ (Tel. 66 40 100)
14:00 DOM ST. MARIEN: Glockenführung, stündlich bis 16:00
14:00 DOM ST. MARIEN: Domführung
15:00 KLEINE SYNAGOGE: Öffentliche Führung i
17:30 BESUCHERZENTRUM ZITADELLE
PETERSBERG: Funzelführung
REGION
16:00
20:00
NIEDERZIMMERN/HOFTHEATER: Open Air: Hans im Glück


SAALFELD/HOHER SCHWARM: Open Air: Klangzauber unterm Sternenzelt

34
JuliTERMINE SO 16.
STADTGARTEN
THEATER
KAUFMANNSKIRCHE
KINOKLUB
: Living – Einmal wirklich leben
KINOKLUB
: The Art of Love (GB/CH, 2022)
DOMPLATZ
: DomStufen-Festspiele: Fausts Verdammnis – Oper von Hector Berlioz
KINOKLUB
KIRCHE
CRUCISKIRCHE
Messe
REGLERKIRCHE: Gottesdienst
ST. SEVERI: Hl. Messe 11/18 DOM ST. MARIEN: Gottesdienst
09:30 AUGUSTINERKLOSTER: Rosenfest
MAISLABYRINTH ERFURT: Familientag
: Mein fabelhaftes Verbrechen
08:00
: Hl.
09:30
09:30
FREIZEIT
10:00
NATURKUNDEMUSEUM: Schlaumeierquiz
SONDERHALTESTELLE
DOMPLATZ SÜD: Altstadt-Express, stündlich bis 15:30 11/15 BESUCHERZENTRUM ZITADELLE
PETERSBERG: Geheimnisvolle Wege...
ERFURT
SONDERHALTESTELLE
Foto: Christoph Köstlin
Foto: Stadtverwaltung Erfurt
KULTUR
10:00 FRANZ MEHLHOSE: 10. Ferien Band Projekt
12:00 KAUFMANNSKIRCHE: 20 Min. Orgelmusik
16:40 KINOKLUB: Das Lehrerzimmer (DE, 2022)
18:40 KINOKLUB: Living – Einmal wirklich leben
20:40 KINOKLUB: The Art of Love (GB/CH, 2022)
KIRCHE
18:00 DOM ST. MARIEN: Abendmesse

FREIZEIT
06:30 DOMPLATZ: Frischwarenmarkt
08:30 MYTAOGARDEN AKADEMIE: Millieugestaltung-Beraterausbildung
08:30 ZOOPARK: Sommerferienspiele 2023

10:00 KULTURHOF KRÖNBACKEN: Workshop
„Ferien-Fashion für alle – Textile Experimente und gerechte Mode“ – ab 13 Jahren
THEATER-TIPP:
10:00
MAISLABYRINTH: Biergarten&BrezelTag

10:00 STADTMUSEUM: Geocaching
11/15
BESUCHERZENTRUM ZITADELLE
PETERSBERG: Geheimnisvolle Wege...
11/14 ERFURT TOURIST INFO: Altstadtführung
11:00 KAUFMANNSKIRCHE: Die Kaufmannskirche –ein verborgener Schatz
11/14 SONDERHALTESTELLE DOMPLATZ SÜD: Erfurt-Tour: Fahrt mit der hist. Straßenbahn
12:15 ELISABETHKAPELLE: Führung
14:00 DOM ST. MARIEN: Domführung

17:00 MYTAOGARDEN AKADEMIE: Vortrag: Gesundheitswerte verbessern mit unserem Stoffwechselprogramm?
17:30 BESUCHERZENTRUM ZITADELLE PETERSBERG: Funzelführung
DER GLÖCKNER VON
NOTRE DAME
1.–29.7.2023, Mi – Sa, 21 Uhr, 2.–26.8.2023, Mi – Sa, 20 Uhr
Innenhof Angermuseum
Alle Tickets für Veranstaltungen sind auch in der ERFURT TOURIST INFORMATION
am Benediktsplatz 1 (zwischen Rathaus und Krämerbrücke) erhältlich – Tel. 0361/66 40 100.
Für die Pariser Feuerwehr ist keine Herausforderung zu groß und deshalb schwingen sich unsere waghalsigen Helden auf ihre Drehleiter und entfachen ein fantasievolles Spektakel, um Ihre Herzen für diese berührende Geschichte zu entflammen.
Dauer: 90 min + Pause

35 JuliTERMINE
MO 17. im Stadtplan C2 Augustiner an der Krämerbrücke Horngasse 3 – 4 99084 Erfurt Tel. 0361 6019070 info@augustiner-erfurt.de
Tickets: (0361) 66 40 100
Foto: Anton Peschel


Alle Stadtbahn-Linien verkehren montags bis freitags von 06:00 bis 18:00 Uhr im 10-Minuten-Takt.
Europaplatz
Thüringen-Park
Straße der Nationen
Warschauer Str.
Mainzer Str. Rieth
Nordbahnhof
Vilniuser Str. Mittelhäuser Str.
Berliner Str.
Ilversgehofener Platz
Riethstr.
Klinikum
Universität
Baumerstr.
Bundesarbeitsgericht
Bergstr.
Wendenstr.
Lutherkirche/ SWE
Boyneburgufer
Zoopark
Roter Berg
AugustFrölich-Str.
Bunsenstr.
An der Lache
Grubenstr.
Neusißstr.
Schwimmhalle Johannesplatz
Salinenstr. Eislebener Str.
Fritz-BüchnerStr.
Steinplatz
Augustinerkloster
Webergasse/ Andreaskirche Stadtmuseum/ Kaisersaal
Domplatz Nord
Ringelberg
Wagenfeldstr.
MarcelBreuer-Ring
Bautzener Weg
Krämpfer Gärten
Greifswalder Str.
Hanseplatz/FH
Leipziger Platz
Fischmarkt/ Rathaus
Gamstädter Weg Angerbrunnen
Justizzentrum
Nibelungenweg
WalterGropiusSchule Volkenroder Weg
Hauptfriedhof
Gothaer Platz
egapark
Theater Anger
S-Finanzzentrum

Domplatz Süd Lange Brücke
Brühler Garten
Krämpfertor Gorkistr.
KarlMarxPlatz
Hirschgarten
Ruhrstr.
Hauptbahnhof
Spielbergtor
Robert-Koch-Str.
Kaffeetrichter
Hochheimer Str.
Steigerstr.
Puschkinstr.
Milchinselstr.
Landtag/ Stadion Nord
Geraer Str.
Tschaikowskistr.
Orionstr.
Flughafen/Airport
Am Kreuzchen Messe
Büropark AIRFURT
Bindersleben
mdr/Kinderkanal
Humboldtstr.
Thüringenhalle
P+R-Platz Messe
Stadion Ost
Am Schwemmbach Sozialversicherungszentrum
Blücherstr.
Abzweig Wiesenhügel
Färberwaidweg
Wiesenhügel
Immer mobil mit der EVAG-App! Abfahrten in Echtzeit I Aktuelle Meldungen I Abo abschließen und verwalten www.evag.app
Jenaer Str.
Häßlerstr.
Thielenstr.
Daberstedt
Melchendorf
Melchendorfer Markt
Drosselberg
Katholisches Krankenhaus
Windischholzhausen/ X-FAB
Urbicher Kreuz
Redaktionsschluss: März 2022, Änderungen vorbehalten. Infografik: Baumgardt Consultants GbR, www.baumgardt-online.de Erfurter Verkehrsbetriebe AG Service-Telefon: 0361 19449 www.evag-erfurt.de evag@stadtwerke-erfurt.de gültig ab: 14.3.2022 6 - 18 Uhr Flutgraben Gera Wilde egapark HugoPreuß-Platz Stadtpark RingGagarin-J.Schillerstr. Goethestr. H.-Mann-Str. R.-Koch-Str. Herderstr. F.-List-Str. Löberwallgraben Puschkinstr.DalbergswegKartäuserstr. Walkmühlstr. Hirschlachufer BrühlerStr. Str.desFriedens Rudolfstr. Heinrichstr. Binderslebener Landstr. Borntalweg Fröbelstr.Stolzestr. WegWitterdaer Biereyestr. Lauentor Blumenstr.SchwarzburgerStr.NordhäuserStr. Andreasstr. Moritzstr. Am Hügel Schmidstedter Str. Moritzwallstr. Bergstr. Bebelstr.F.-Büchner-Str. Talstr. Magdeburger Allee Johannesstr. bergallee StauffenbergalleeStauffenSchillerstr. 5 5 6 4 3 51 58 60 95 111 812 1 3 4 6 20 30 2 65 9 9 2 80 1
GeschwisterScholl-Str. WilhelmBusch-Str.
KULTUR
10:00 FRANZ MEHLHOSE: 10. Ferien Band Projekt
16:40 KINOKLUB: Das Lehrerzimmer (DE, 2022)
17:00 ANDREASKIRCHE: 20 Minuten Orgelmusik
18:40 KINOKLUB: Living – Einmal wirklich leben
20:30 DOMPLATZ: DomStufen-Festspiele: Fausts
Verdammnis - Oper von Hector Berlioz
20:40 KINOKLUB: The Art of Love (GB/CH, 2022)
KIRCHE
18:00 DOM ST. MARIEN: Abendmesse
18:00 ELISABETHKAPELLE: Abendandacht
SPORT
17:30 EGAPARK: Bodybalance mit der AOK Plus
FREIZEIT
06:30 DOMPLATZ: Frischwarenmarkt
08:30 MYTAOGARDEN AKADEMIE: Millieugestaltung-Beraterausbildung
08:30 ZOOPARK: Sommerferienspiele 2023
10:00 KULTURHOF KRÖNBACKEN: Workshop
„Ferien-Fashion für alle – Textile Experimente und gerechte Mode“ – ab 13 Jahren
10:00 MAISLABYRINTH: Sport & SpieleTag –Tischtennis / Kicker / Darts
10:00 NATURKUNDEMUSEUM: Zeichenworkshop
„Lebenstraum Phantasie“
10:00 STADTMUSEUM: Tücher färben
11/15 BESUCHERZENTRUM ZITADELLE
PETERSBERG: Geheimnisvolle Wege durch die barocke Stadtfestung
11/14 ERFURT TOURIST INFO: Altstadtführung
11/14 SONDERHALTESTELLE DOMPLATZ SÜD: Erfurt-Tour: Fahrt mit der historischen Straßenbahn
14:00 DOM ST. MARIEN: Domführung

17:00 MYTAOGARDEN AKADEMIE: Frauenplausch
17:00 STADTMUSEUM: Führung: „Modell Innenstadt. Planungen für die Mitte von Erfurt“
17:30 BESUCHERZENTRUM ZITADELLE
PETERSBERG: Funzelführung mit Taschenlampen in den Horchgängen
Erfurt – die Faszination einer historischen Stadt erleben
Für Erfurt sollten Sie sich Zeit nehmen, denn die Stadt ist mehr als eine Reise wert. Die Sehenswürdigkeiten lernen Sie am besten bei einer Stadtführung kennen. Erfurt ist nicht nur die größte Stadt Thüringens. Erfurt ist auch eine äußerst beeindruckende und sehenswerte Stadt im Herzen Deutschlands. Nicht umsonst sagte bereits Dr. Martin Luther: Erfurt „liegt am besten Ort. Da muss eine Stadt stehen”. Die Wahrzeichen der Stadt sind das Ensemble von Dom St. Marien und der St. Severi Kirche. Sie prägen das Stadtbild wie kaum eine andere Sehenswürdigkeit in Erfurt. Eine Attraktion der Stadt ist die Krämerbrücke. Sie führt auf 120 m über den Fluss Gera und ist mit 32 Häusern bebaut – damit zählt sie zu den längsten komplett bebauten und bewohnten Brücken Europas.
Es erwartet Sie ein interessanter Spaziergang durch die Altstadt (ohne Innenbesichtigungen).
Täglich um 11 und 14 Uhr. Zusätzliche Kurzführung Fr/Sa 16 Uhr.
Marktstraße 50, 99084 Erfurt
Telefon: 0361/ 5 61 35 06 www.rade-erfurt.de
39 JuliTERMINE DI 18. im Stadtplan C3
Wir sind Spezialisten der Thüringer Küche mit idyllischem Biergarten im Innenhof
www.rade-erfurt.de
Foto: ETMG/B. Neumann
VERLOSUNG:
SOMMERKOMÖDIE
„Der Menschenfeind oder der verliebte Melancholiker“
27.7. bis 27.8.2023, Barfüßerruine
Der Adelige Alceste ist ein überzeugter Verächter der besseren Gesellschaft, die von Heuchelei und Hedonismus durchsetzt ist.
Daher beschließt er fortan allen die Wahrheit zu sagen, sei sie noch so unhöflich und verletzend. Während er mit diesem Verhalten die Ungunst seines Umfeldes auf sich zieht, verliebt er sich in die kokette Célimène.
Molière ist durch seine Komödien weltbekannt und offenbart sich in seinem Werk zugleich als außerordentlicher Menschenkenner. Erleben Sie sein rasantes Meisterwerk über den verliebten Misanthropen an einem lauen Sommerabend in der Erfurter Barfüßerruine.
Veranstaltungsort:
Barfüßerkirche, Barfüßerstraße 20
verlost:ERFURT magazin
2 x 2 Freikarten für „DER MENSCHENFEIND“ (30.7.2023, 21 Uhr)
Teilnahme: Nur am 19.7., 10 – 18 Uhr in der Erfurt Tourist Information oder unter www.erfurt-magazin.info
KULTUR
10:00 DOMPLATZ: DOMINO – DomStufen-Festspiele für die Kleinen: Jim Knopf und Lukas der Lokomotivführer
10:00 FRANZ MEHLHOSE: 10. Ferien Band Projekt
12:00 KUNSTHALLE: Kunstpause
13:00 ANGERMUSEUM: Kunstpause
16:40 KINOKLUB: Das Lehrerzimmer (DE, 2022)
18:40 KINOKLUB: Living – Einmal wirklich leben
19:30 HAUS DACHERÖDEN: Kino im Salon | Erlesene Filme: Der Pfad i

20:00 PREDIGERKIRCHE: Orgelkonzert
20:30 DOMPLATZ: DomStufen-Festspiele: Fausts Verdammnis – Oper von Hector Berlioz
20:40 KINOKLUB: The Art of Love (GB/CH, 2022)
21:00 ANGERMUSEUM: Der Glöckner von Notre Dame (Tel. 0361/66 40 100)
KIRCHE
18:00 DOM ST. MARIEN: Abendmesse
SPORT
17:00 SÜDPARK: Sport im Park
FREIZEIT
06:30 DOMPLATZ: Frisch- und Hartwarenmarkt
08:30 MYTAOGARDEN AKADEMIE: Millieugestaltung-Beraterausbildung
08:30 ZOOPARK: Sommerferienspiele 2023
10:00 FLUGHAFEN: FlughafenFerienTour
10:00 KULTURHOF KRÖNBACKEN: Workshop
„Ferien-Fashion für alle – Textile Experimente und gerechte Mode“ – ab 13 Jahren
10:00
NATURKUNDEMUSEUM: Schlaumeierquiz
11/15 BESUCHERZENTRUM ZITADELLE
PETERSBERG: Geheimnisvolle Wege durch die barocke Stadtfestung
11/14 ERFURT TOURIST INFO: Altstadtführung
11/14
SONDERHALTESTELLE DOMPLATZ SÜD: Erfurt-Tour: Fahrt mit der historischen Straßenbahn
14:00 DOM ST. MARIEN: Domführung
14:30 DOMPLATZ: Kulinarische Stadtführung
„Erfurt macht blau“ (Tel. 0361 /66 40 100)


15:00 DOMSCHATZKAMMER: Führung
17:30 BESUCHERZENTRUM ZITADELLE
PETERSBERG: Funzelführung mit Taschenlampen in den Horchgängen
21:00 MAISLABYRINTH: Nachtwanderung
40
JuliTERMINE MI 19.
Foto: SOKO Erfurt, Lutz Edelhoff
Foto: SOKO Erfurt, Lutz Edelhoff
KULTUR
10:00 FRANZ MEHLHOSE: 10. Ferien Band Projekt
17:00 KINOKLUB: Die Purpursegel (FR/IT/DE/RU, 22)
19:00 KINOKLUB: Die Unschärferelation der Liebe (DE, 2023)
19:30
KINO-TIPPS:
20. bis 26. Juli 2023 im Kinoklub am Hirschlachufer
BARFÜSSERKIRCHE: Erfurt in Licht und Schatten (Tel. 0361/66 40 100)
19:30 HAUS DACHERÖDEN: Bhutan. Ein bebilderter Reisebericht von Evelyn Bierbach
20:30 DOMPLATZ: DomStufen-Festspiele: Fausts Verdammnis – Oper von Hector Berlioz
20:50 KINOKLUB: Pearl (OmU, CA/USA, 2023)
21:00 ANGERMUSEUM: Der Glöckner von Notre Dame (Tel. 0361/66 40 100)
KIRCHE
18:00
AUGUSTINERKIRCHE: Abendgebet / engl.
18:00 DOM ST. MARIEN: Abendmesse
SPORT
17:30
EGAPARK ERFURT: Yoga mit der AOK Plus
FREIZEIT
06:30 DOMPLATZ: Frischwarenmarkt
08:30 MYTAOGARDEN AKADEMIE: Millieugestaltung-Beraterausbildung
08:30 ZOOPARK: Sommerferienspiele 2023
09:00 DOM ST. MARIEN: Glockenführung, stündlich bis 13:00
10:00 KULTURHOF KRÖNBACKEN: Workshop
„Ferien-Fashion für alle – Textile Experimente und gerechte Mode“ – ab 13 Jahren
10:00 NATURKUNDEMUSEUM: Schlaumeierquiz
10:30 SONDERHALTESTELLE DOMPLATZ SÜD: Altstadt-Express – Fahrt mit dem Gelenkbus, stündlich bis 15:30
11/15
11/14
11/14
BESUCHERZENTRUM ZITADELLE
PETERSBERG: Geheimnisvolle Wege durch die barocke Stadtfestung
ERFURT TOURIST INFORMATION: Altstadtführung Erfurt – Die Faszination einer historischen Stadt erleben
SONDERHALTESTELLE DOMPLATZ SÜD: Erfurt-Tour: Fahrt mit der hist. Straßenbahn
14:00 DOM ST. MARIEN: Domführung
14:00 DOMPLATZ: Kulinarische Stadtführung
„Andreasviertel-Tour“ (Tel. 0361 /66 40 100)
14:00 WENIGEMARKT: Kulinarische Stadtführung
„Altstadt-Tour“ (Tel. 0361 /66 40 100)
17:30 BESUCHERZENTRUM ZITADELLE
PETERSBERG: Funzelführung mit Taschenlampen in den Horchgängen
18:00 CAPONNIERE RESTAURANT IM EGAPARK: Weinwochen „Grillen & Wein“
18:00 KUNSTHALLE: Führung durch die Ausstellung
„Engelberg + Inszenierte Fotografie“
18:00 MAISLABYRINTH ERFURT: Lagerfeuer & Stockbrot ab Sonnenuntergang + Biergarten
20:00 ERFURT TOURIST INFORMATION: Romantischer Abendspaziergang…
20.–22.7., 17.00 / 24.–26.7., 18.50: Die Purpursegel (FR/IT/DE/RU, 2022) Normandie, 1919: Raphaël (Raphaël Thiéry), ein ehemaliger Soldat, und seine kleine Tochter Juliette leben zurückgezogen im Norden Frankreichs. Eines Sommers lernt das Mädchen einen Jungen in ihrem Alter kennen: Jean ist ein wohlhabender Erbe. Zwischen diesen beiden verträumten Kindern wird ein geheimer Pakt geschlossen, der die Zeit und die Tragödie überdauern wird... i

20.–22.7., 19.00 / 24.–26.7., 17.00: Die Unschärferelation der Liebe (DE, 2023) Greta (Caroline Peters) ist Schulsekretärin. Sie ist laut, impulsiv, spontan und einsam. Ein Schicksal, das sie mit dem Metzgermeister Alexander (Burghart Klaußner) teilt. Doch im Gegensatz zu ihr ist er ruhig, korrekt und liebt seine Routinen. Trotz ihrer vielen Unterschiede beginnt zwischen ihnen eine Liebe. Und beide fragen sich, was sie noch vom Leben erwarten.
20.–22.7., 20.50 (OmU) / 24.–26.7., 20.50: Pearl (CA/USA, 2023) Im Jahr 1918, kurz vor Ende des ersten Weltkrieges, lebt Pearl (Mia Goth) auf einer abseits gelegenen texanischen Farm, während ihr Mann im Krieg dient. Ihrem harten Alltag steht die große Sehnsucht nach einem glamourösen Leben gegenüber, das sie im örtlichen Kino sieht. Der nahezu unerreichbare Traum bietet den perfekten Nährboden für unterdrückte Gefühle und Triebe, die mit psychotischem Wahn und Mordfantasien zusammenprallen.
41
DO
JuliTERMINE
20.
VORSCHAU-TIPP:
FR 21.
KULTUR
10:00 FRANZ MEHLHOSE: 10. Ferien Band Projekt
14:00 KINOKLUB: Kino für Senioren: Alma & Oskar (DE/AT/CH/CZ, 2021)
17:00 KINOKLUB: Die Purpursegel (FR/IT/DE/RU, 22)
19:00 GALLI THEATER: Schlagersüßtafel –Eine gesamtdeutsche Komödie
19:00 KINOKLUB: Die Unschärferelation der Liebe (DE, 2023)
19:30 BARFÜSSERKIRCHE: Erfurt in Licht und Schatten (Tel. 0361/66 40 100)
19:30 HAUS DACHERÖDEN: SWE SPECIAL –
9. Thüringer Diary Slam
PYRO GAMES 2023

2.9.2023, 18 Uhr, Messegelände
Am 02. September 2023 wartet ein Pyro-Spektakel mit glitzernden Sternen, leuchtenden Kometen und in den nachtblauen Himmel wachsenden Feuerwerksblüten auf die Besucher. Faszination Feuerwerk in seiner schönsten Effektvielfalt erleuchtet das Messegelände in Erfurt.
Deutschlandweit stellen sich gleich drei Pyroprofis mit ihren Teams dem Kampf um die goldene Trophäe der Feuerwerkskunst und lassen mit ihren fesselnden Darbietungen den Abendhimmel in allen Regenbogenfarben leuchten. Sensationelle Pyro-Effekte, eine außergewöhnliche Brillanz und die Leuchtkraft der Farben in perfekter Abstimmung zur Musik werden das Publikum begeistern.
Der Fokus liegt aber nicht nur auf den Pyro Shows. Neben dem Wettbewerb mit grandiosen Boden- und Höhenfeuerwerken stehen Unterhaltung und ein familiengerechtes Abendprogramm im Vordergrund. Live-Musik, Walking-Acts und Feuershow prägen die bunte Szenerie. Überdimensionale Stelzenläufer empfangen die kleinen und großen Besucher.
Ein weiteres Highlight ist die atemberaubende Licht- und Lasershow des MultimediaLaser-Feuerkünstlers Jürgen Matkowitz, dem Inhaber von Apollo Art of Laser and Fire. Die Zuschauer werden eine auf die Pyro Games zugeschnittene, musiksynchrone und spektakuläre Lasershow erleben.
Tickets: (0361) 66 40 100
20:00 FORSTHAUS WILLRODA: Open Air: Mord im Morgengrauen
20:30 DOMPLATZ: DomStufen-Festspiele: Fausts Verdammnis – Oper von Hector Berlioz
20:50 KINOKLUB: Pearl (OmU, CA/USA, 2023)
21:00 ANGERMUSEUM: Der Glöckner von Notre Dame (Tel. 0361/66 40 100) m
21:30 KULTURHOF KRÖNBACKEN: Open Air: Asteroid City (USA, 2023)
23:00 ENGELSBURG: Rave Rave Rave
KIRCHE
12:00
18:00
: Friedensgebet
08:30
: Sommerferienspiele 2023
10:00 KULTURHOF KRÖNBACKEN: Workshop „Ferien-Fashion für alle – Textile Experimente und gerechte Mode“ – ab 13 Jahren
10:00 NATURKUNDEMUSEUM: Schlaumeierquiz
10:00 VOLKSKUNDEMUSEUM: Offene Druckwerkstatt
10:30 SONDERHALTESTELLE DOMPLATZ SÜD: Altstadt-Express – Fahrt mit dem Gelenkbus, stündlich bis 15:30
11/15 BESUCHERZENTRUM ZITADELLE
PETERSBERG: Geheimnisvolle Wege durch die barocke Stadtfestung
11/14
11/14/16
ERFURT TOURIST INFORMATION: Altstadtführung Erfurt – Die Faszination einer historischen Stadt erleben
SONDERHALTESTELLE DOMPLATZ SÜD: Erfurt-Tour: Fahrt mit der historischen Straßenbahn
12/14/15 DOM ST. MARIEN: Glockenführung
13:00 DOM ST. MARIEN: Führungen zum Marienmosaik
14:00 DOM ST. MARIEN: Domführung
14:30
14:30
DOMPLATZ: Kulinarische Stadtführung
„Andreasviertel-Tour“ (Tel. 0361 /66 40 100)
WENIGEMARKT: Kulinarische Stadtführung
„Altstadt-Tour“ (Tel. 0361 /66 40 100)
42 Juli
TERMINE
AUGUSTINERKLOSTER
DOM
FREIZEIT
DOMPLATZ:
MYTAOGARDEN AKADEMIE
gestaltung-Beraterausbildung
ST. MARIEN: Abendmesse
06:30
Frisch- und Hartwarenmarkt 08:30
: Millieu-
ZOOPARK
16:00 ERFURT TOURIST INFORMATION: Kurzführung – Historische Altstadt
17:30 BESUCHERZENTRUM ZITADELLE
PETERSBERG: Funzelführung mit Taschenlampen in den Horchgängen
18:00 CAPONNIERE RESTAURANT IM EGAPARK: Weinwochen „Grillen & Wein“
18:00 MAISLABYRINTH: DJ LOUNGE Chillige Musik
18:00 ZITADELLE PETERSBERG: Rundgang mit dem Petersberger Schwarzbrenner (Tel: 66 40 100)
18:30 LÉGÈRE HOTEL: Food & Beat: Urlaub im Orient
19:00 ZUGHAFEN: Charlie Moskau On Air
20:00 ERFURT TOURIST INFORMATION: Romantischer Abendspaziergang …
20:00 VINARIUM: Seminar: Drink pink – Rosé von fein und elegant bis kräftig und dominant
21:00 AUGUSTINERKLOSTER: Luthers schlaflose Nächte in Erfurt (Tel. 0361/66 40 120)

DER GLÖCKNER VON NOTRE DAME
Für die Pariser Feuerwehr ist keine Herausforderung zu groß und deshalb schwingen sich unsere waghalsigen Helden auf ihre Drehleiter und entfachen ein fantasievolles Spektakel, um Ihre Herzen für diese berührende Geschichte zu entflammen.

30.06. bis 26.08.2023
Mittwoch bis Samstag: 20:00 oder 21:00 Uhr
Veranstaltungsort
Innenhof Angermuseum
Dauer
ca. 90 min + Pause
FR 21.
KULTUR
10/14
DOMPLATZ: DOMINO – DomStufenFestspiele für die Kleinen 2023: Jim Knopf und Lukas der Lokomotivführer
11:00 FESTUNGSBÄCKEREI: Open Air: Der Froschkönig
16:00
JAZZCLUB: GRAPHIT Battle meets JAZZ
17:00 KINOKLUB: Die Purpursegel (FR/IT/DE/RU, 2022)
18:00 FRANZ MEHLHOSE: 10. Ferien Band Projekt
19:00 GALLI THEATER: Schlagersüßtafel –Eine gesamtdeutsche Komödie
19:00 KINOKLUB: Die Unschärferelation der Liebe (DE, 2023)
19:30
19:30
BARFÜSSERKIRCHE: Erfurt in Licht und Schatten (Tel. 0361/66 40 100)
KABARETT PUFFBOHNE: Kabarett Erfurter Puffbohne „Am Anfang war es schön“
20:00 DASDIE BRETTL: Tanzparty für Singles und Paare
20:00 FORSTHAUS WILLRODA: Open Air: Mord im Morgengrauen
20:00 HEILIGEN MÜHLE: Panik Syndikat –Udo Lindenberg Tribute Show
20:30 DOMPLATZ: DomStufen-Festspiele: Fausts Verdammnis – Oper von Hector Berlioz
20:30
NATURKUNDEMUSEUM: Der kleine Prinz –Unterwegs zu den Sternen (Tel. 66 40 120)
20:50 KINOKLUB: Pearl (OmU, CA/USA, 2023)
21:00 ANGERMUSEUM: Der Glöckner von Notre Dame (Tel. 0361/66 40 100)
21:30
EGAPARK ERFURT: Sommerkino: Einfach mal was Schönes
21:30 KULTURHOF KRÖNBACKEN: Open Air im Krönbacken: Die Insel der Zitronenblüten (ES/LX, 2020)
22:00 CLUB CENTRAL: 8 Jahre Tekk is Back
22:00 CLUB PALAIS: Boom Boom – Mega 90er und 2000er Party
23:00 ENGELSBURG: All you can dance
KIRCHE
18:00 AUGUSTINERKIRCHE: Abendgebet
18:00 DOM ST. MARIEN: Vesper
18:00 KAUFMANNSKIRCHE: Abendsegen und Orgelmusik
SPORT
16:30 STEIGERWALDSTADION: FC Rot-Weiß Erfurt – Borussia Dortmund

FREIZEIT
06:30 DOMPLATZ: Frisch- und Hartwarenmarkt
08:30 MYTAOGARDEN AKADEMIE: Liebe & Partnerschaft mit FengShui
10:00 MAISLABYRINTH: Familien Tag
10:00 NATURKUNDEMUSEUM: Schlaumeierquiz
10:15 ALTE SYNAGOGE: Öffentliche Führung
10:30 SONDERHALTESTELLE DOMPLATZ SÜD: Altstadt-Express – Fahrt mit dem Gelenkbus, stündlich bis 15:30
11/15 BESUCHERZENTRUM ZITADELLE
PETERSBERG: Geheimnisvolle Wege durch die barocke Stadtfestung
11/12 DOM ST. MARIEN: Turm- und Glockenführung
11/14 ERFURT TOURIST INFORMATION: Altstadtführung Erfurt – Die Faszination einer historischen Stadt erleben
11/14/16 SONDERHALTESTELLE DOMPLATZ SÜD: Erfurt-Tour: Fahrt mit der historischen Straßenbahn
11:00 WILDKRÄUTERKOCHSCHULE: Essbare Blüten & Rosenelexier
11:00 AUGUSTINERKLOSTER: Lebenslust und Seelenqualen – Luther in Erfurt (Tel. 66 40 120)
11:45 MIKWE: Öffentliche Führung
13:00 DOM ST. MARIEN: Führung Marienmosaik
13/14 DOMPLATZ: Kulinarische Stadtführung
„Andreasviertel-Tour“ (Tel. 0361 /66 40 100)
13:30 WENIGEMARKT: Kulinarische Stadtführung
„Altstadt-Tour“ (Tel. 66 40 100), auch 14:30
14/15/16 DOM ST. MARIEN: Glockenführung
14:00 DOM ST. MARIEN: Domführung
14:30 DOMPLATZ: Kulinarische Stadtführung
„Erfurt macht blau“ (Tel. 0361 /66 40 100)
15:00 DOMSCHATZKAMMER: Führung
15:00 VINARIUM: Rundgang durch die Aroma-Arena
16:00 ERFURT TOURIST INFORMATION:
17:00
17:30
Kurzführung – Historische Altstadt
DESTILLE: Brennereiführung mit Verkostung
BESUCHERZENTRUM ZITADELLE
PETERSBERG: Funzelführung mit Taschenlampen in den Horchgängen
20:00 ERFURT TOURIST INFORMATION: Romantischer Abendspaziergang…
REGION
10:30 WASSERBURG KAPELLENDORF: Open Air: Rotkäppchen
JuliTERMINE SA 22. 44
f
KULTUR
10:00
DOMPLATZ: DOMINO – DomStufenFestspiele für die Kleinen: Jim Knopf und Lukas der Lokomotivführer
11:00 STADTGARTEN: Open Air: Dornröschen
20:30 DOMPLATZ: DomStufen-Festspiele: Fausts Verdammnis – Oper von Hector Berlioz
KIRCHE
08:00 CRUCISKIRCHE: Hl. Messe
09:30 AUGUSTINERKLOSTER: Gottesdienst
09:30 REGLERKIRCHE: Gottesdienst
09:30 ST. SEVERI: Hl. Messe
11/18 DOM ST. MARIEN: Gottesdienst
FREIZEIT
08:30 MYTAOGARDEN AKADEMIE: Liebe & Partnerschaft mit FengShui
10:00 MAISLABYRINTH ERFURT: Familien Tag

10:00 MYTAOGARDEN AKADEMIE: Mit Pinsel & Papier Energiebilder malen für Jedermann
10:00




10:30
11/15
NATURKUNDEMUSEUM: Schlaumeierquiz
SONDERHALTESTELLE DOMPLATZ SÜD: Altstadt-Express , stündlich bis 15:30
BESUCHERZENTRUM ZITADELLE
PETERSBERG: Geheimnisvolle Wege...
11/14 ERFURT TOURIST INFO: Altstadtführung
11/14 SONDERHALTESTELLE DOMPLATZ SÜD: Erfurt-Tour: Fahrt mit der hist. Straßenbahn i

13/14 DOMPLATZ: Kulinarische Stadtführung
„Historische Sonntags-Tour“ (Tel. 66 40 100)


14/15/16 DOM ST. MARIEN: Glockenführung

14:00 DOM ST. MARIEN: Domführung
15:00 FLUGHAFEN: FlughafenSonntagsTour
















17:30 BESUCHERZENTRUM ZITADELLE PETERSBERG: Funzelführung
REGION
16:00 NIEDERZIMMERN/HOFTHEATER: Open Air: Rotkäppchen
45
TERMINE SO 23.
Juli
VORSCHAU-TIPPS:
ADEL TAWIL

6.10.2023, 20 Uhr, Messehalle
„Lieder“, „So schön anders“, „Alles Lebt“ –jede Tour, jedes Konzert ist ein unvergessliches Live-Erlebnis. Inzwischen hat Adel Tawil zusammen mit seiner Band vor über zwei Millionen Zuschauern gespielt und freut sich, ein weiteres Kapitel aufzuschlagen.
NINO DE ANGELO
8.10.2023, 19 Uhr, Messehalle
Ist es möglich nach einer langen und erfolgreichen Karriere alles hinter sich zu lassen, und sich noch einmal ganz neu zu erfinden?
Genau das ist Nino de Angelo gelungen!
Mit epochalen Songs und emotionsstarken
Texten begeisterte er die eigenen Fans: Nino de Angelo geht erstmalig in seiner langen Karriere im Oktober 2023 auf Deutschland Tournee.
Unter dem Motto „Von Ewigkeit zu Ewigkeit“ präsentiert er seine neuen Songs, und gewährt damit schonungslose Einblicke in seine Gedanken und in sein Leben.
Tickets: (0361) 66 40 100
GEHEIMNISVOLLE WEGE DURCH DIE BAROCKE STADTFESTUNG
Die Horchgänge in der Zitadelle Petersberg sollten die Festung vor Eindringlingen schützen. Wenn der Feind einen Tunnel in den Berg gegraben hatte, wurde Alarm geschlagen, um die Zitadelle zu verteidigen. Wie fühlten sich die Soldaten, wenn sie in den dunklen Gängen an den Mauern lauschten?

Folgen Sie unseren Stadtführern und erfahren Sie interessante Fakten über die wechselvolle Geschichte dieses beeindruckenden Bauwerks.
Täglich 11 und 15 Uhr.
KULTUR
12:00 KAUFMANNSKIRCHE: 20 Min. Orgelmusik
17:00 KINOKLUB: Die Unschärferelation der Liebe (DE, 2023)
18:50 KINOKLUB: Die Purpursegel (FR/IT/DE/RU, 22)
20:50 KINOKLUB: Pearl (CA/USA, 2023)

KIRCHE
18:00 DOM ST. MARIEN: Abendmesse
FREIZEIT
06:30 DOMPLATZ: Frischwarenmarkt
09:00 KULTURHOF KRÖNBACKEN: Workshop „Farben für Alle – Action Painting“ – ab 11 Jahren
10:00
11/15
11/14
11:00
11/14
12:15
MAISLABYRINTH: Biergarten&BrezelTag
BESUCHERZENTRUM ZITADELLE
PETERSBERG: Geheimnisvolle Wege durch die barocke Stadtfestung h
ERFURT TOURIST INFORMATION: Altstadtführung Erfurt – Die Faszination einer historischen Stadt erleben
KAUFMANNSKIRCHE: Die Kaufmannskirche –ein verborgener Schatz
SONDERHALTESTELLE DOMPLATZ SÜD: Erfurt-Tour: Fahrt mit der historischen Straßenbahn
ELISABETHKAPELLE IM NIKOLAITURM: Führung in der Elisabethkapelle
14:00 DOM ST. MARIEN: Domführung
17:30
BESUCHERZENTRUM ZITADELLE
PETERSBERG: Funzelführung mit Taschenlampen in den Horchgängen
46 JuliTERMINE MO 24.
Foto: Tom Wagner
Foto: Maximilian König
Foto: ETMG / B. Neumann
KULTUR
17:00 ANDREASKIRCHE: 20 Minuten Orgelmusik

17:00 KINOKLUB: Die Unschärferelation der Liebe (DE, 2023)
18:50 KINOKLUB: Die Purpursegel (FR/IT/DE/RU, 2022)
20:50 KINOKLUB: Pearl (CA/USA, 2023)
KIRCHE
18:00 DOM ST. MARIEN: Abendmesse
18:00
ELISABETHKAPELLE IM NIKOLAITURM: Abendandacht
SPORT
17:30 EGAPARK: Bodybalance mit der AOK Plus
FREIZEIT
06:30 DOMPLATZ: Frischwarenmarkt
08:30 MYTAOGARDEN AKADEMIE: Gesundheitstag für Ihr Unternehmen
09:00 KULTURHOF KRÖNBACKEN: Workshop „Farben für Alle – Action Painting“ – ab 11 Jahren
10:00 MAISLABYRINTH ERFURT: Sport & SpieleTag – Tischtennis / Kicker / Darts
10:00 NATURKUNDEMUSEUM: Schlaumeierquiz
11/15 BESUCHERZENTRUM ZITADELLE PETERSBERG: Geheimnisvolle Wege durch die barocke Stadtfestung
11/14 ERFURT TOURIST INFORMATION: Altstadtführung Erfurt – Die Faszination einer historischen Stadt erleben

11/14 SONDERHALTESTELLE DOMPLATZ SÜD: Erfurt-Tour: Fahrt mit der historischen Straßenbahn
14:00 DOM ST. MARIEN: Domführung
17:30 BESUCHERZENTRUM ZITADELLE PETERSBERG: Funzelführung mit Taschenlampen in den Horchgängen der Zitadelle Petersberg
VORSCHAU-TIPP:
HEAVEN'S GARDEN
26.8.2023, 18 Uhr, Augustinerkirche
Heaven’s Garden, das sind 25 Jahre musikalische Inspiration, explodierende Lebendigkeit, beseelter Groove und hingebungsvolle Stimmen, die singend das Evangelium verkünden.
Als Jugendchor vor über 25 Jahren gegründet, zog Heaven’s Garden Sängerinnen und Sänger verschiedener Altersstufen an. Menschen unterschiedlichster Berufsgruppen frönen mit Lust, Laune, Herzblut und viel Engagement ihrem mitreißenden Hobby.
Längst ist der Chor eine feste Größe bei Veranstaltungen in Erfurt und über die thüringischen Landesgrenzen hinaus bekannt – und das nicht nur in den vielen großen und kleinen Kirchen Erfurts und seiner Umgebung.
Eintritt frei – um Kollekte wird gebeten.
47 JuliTERMINE DI 25. im Stadtplan C3
Bei
ein Genuß !
Dienstag
11.00 Uhr - 14.00 Uhr & 17,00 Uhr
22.30 Uhr
Lange Brücke 53 * Erfurt * & 0361-6 54 77 65 * info@masalaerfurt.de
uns immer-
Montag - Ruhetag
- Sonntag
-
Feine Indische Küche
KULTUR QUARTIER PIONIERE GESUCHT

Werde Mitglied in der 1. Kulturgenossenschaft Thüringens. Jetzt Anteile zeichnen!
OBJEKT
Historisches Gebäude, Baujahr 1897
LAGE
1 A, Innenstadt Erfurt, Klostergang 4
RÄUME
für Kino, Radio, Tanz, Theater, Gastronomie, Ausstellungen ...
GESUCHT
Genossenschaftler*innen mit Weitsicht
KONTAKT
www.kulturquartier-erfurt.de info@kulturquartier-erfurt.de
KULTUR
12:00 KUNSTHALLE: Kunstpause
13:00 ANGERMUSEUM: Kunstpause
14:00 KINOKLUB: Kino für Senioren: Alma & Oskar (DE/AT/CH/CZ, 2021)
16:00 HAUS DACHERÖDEN: Bilderbuchkino: Henri und Henriette fahren in die Ferien h

17:00 KINOKLUB: Die Unschärferelation der Liebe
17:00 VINARIUM: Musik & Wein
18:50 KINOKLUB: Die Purpursegel (FR/IT/DE/RU, 22)
20:00
PREDIGERKIRCHE: Orgelkonzert
20:30 DOMPLATZ: DomStufen-Festspiele: Fausts Verdammnis – Oper von Hector Berlioz
20:50 KINOKLUB: Pearl (CA/USA, 2023)
21:00 ANGERMUSEUM: Der Glöckner von Notre Dame (Tel. 0361/66 40 100)
KIRCHE
18:00 DOM ST. MARIEN: Abendmesse
SPORT
17:00 SÜDPARK: Sport im Park
FREIZEIT
06:30 DOMPLATZ: Frisch- und Hartwarenmarkt
08:30 MYTAOGARDEN AKADEMIE: FengShui Business
09:00 KULTURHOF KRÖNBACKEN: Workshop „Farben für Alle – Action Painting“ – ab 11 Jahren
10:00 FLUGHAFEN: FlughafenFerienTour
10:00
10:00
11/15
jeden 1. Samstag im Monat 16 und 17 Uhr
FÜHRUNGEN DURCHS HAUS
anmeldung@kulturquartier-erfurt.de
11/14
11/14
14:00
14:30
15:00
17:30
NATURKUNDEMUSEUM: Kinderführung
„Kleine Reise zu den Tieren unserer Erde“
NATURKUNDEMUSEUM: Schlaumeierquiz
BESUCHERZENTRUM ZITADELLE
PETERSBERG: Geheimnisvolle Wege...
ERFURT TOURIST INFO: Altstadtführung
SONDERHALTESTELLE DOMPLATZ SÜD: Erfurt-Tour: Fahrt mit der hist. Straßenbahn
DOM ST. MARIEN: Domführung
DOMPLATZ: Kulinarische Stadtführung
„Erfurt macht blau“ (Tel. 0361 /66 40 100)

DOMSCHATZKAMMER: Führung
BESUCHERZENTRUM ZITADELLE
PETERSBERG: Funzelführung
19:00 ENGELSBURG: Kneipenquiz
19:30
HAUS DACHERÖDEN: Tablequiz
48 Juli
TERMINE MI 26.
KULTUR
10:00 DOMPLATZ: DOMINO – DomStufen-Festspiele für die Kleinen 2023: Jim Knopf und Lukas der Lokomotivführer
11:00 KINOKLUB: Sommerferienkino
14:00 KINOKLUB: Sommerferienkino

16:30 KINOKLUB: Mit Liebe und Entschlossenheit (FR, 2022)
18:50 KINOKLUB: Asteroid City (USA, 2023)
19:00 HAUS DACHERÖDEN: Freche Fragen an Ärzte der Zentralklinik Bad Berka
19:00 MAISLABYRINTH: Simon & carfunkel
19:30 HAUS DACHERÖDEN: Kat Menschiks und des Psychiaters Doctor medicinae Jakob Hein Illustrirtes Kompendium der psychoaktiven Pflanzen
20:00 HAUS DER SOZIALEN DIENSTE: Der W
20:30 DOMPLATZ: DomStufen-Festspiele: Fausts Verdammnis – Oper von Hector Berlioz
20:40 KINOKLUB: Die Unschärferelation der Liebe (DE, 2023)
21:00 ANGERMUSEUM: Der Glöckner von Notre Dame (Tel. 0361/66 40 100)
KIRCHE
18:00 AUGUSTINERKIRCHE: Abendgebet / engl.
18:00 DOM ST. MARIEN: Abendmesse
SPORT
17:30 EGAPARK ERFURT: Yoga mit der AOK Plus
FREIZEIT
06:30 DOMPLATZ: Frischwarenmarkt
08:30 MYTAOGARDEN AKADEMIE: FengShui Business
09:00 DOM ST. MARIEN: Glockenführung, stündlich bis 13:00
09:00 KULTURHOF KRÖNBACKEN: Workshop „Farben für Alle – Action Painting“ – ab 11 Jahren
10:00 NATURKUNDEMUSEUM: Schlaumeierquiz
10:30
11/15
KINO-TIPPS:
27. Juli bis 2. August 2023 im Kinoklub am Hirschlachufer
27.–30.7., 16.30 / 31.7.–2.8., 18.30: Mit Liebe und Entschlossenheit (FR, 2022) Jean (Vincent Lindon) und Sara (Juliette Binoche) leben seit zehn Jahren zusammen. Als sie sich kennenlernten, teilte Sara ihr Leben mit François (Grégoire Colin), Jeans bestem Freund. Eines Tages sieht Sara François auf der Straße. Er bemerkt sie nicht, aber sie wird von dem Gefühl überwältigt, dass sich ihr Leben plötzlich ändern könnte. Daraufhin setzt sich eine unkontrollierbare Spirale in Gang...
27.–30.7., 18.50 / 31.7.–2.8., 20.50 (OmU): Asteroid City (USA, 2023) Als vor tausenden von Jahren ein Asteroid auf der Erde einschlug, hinterließ dieser einen tiefen Krater und jede Menge extraterrestrisches Geröll. Dort, im Amerika der 1950er-Jahre, soll der Junior-Stargazer-Kongress stattfinden. Doch stattdessen kommt es zu unerwarteten weltverändernden Ereignissen. Das Militär fackelt nicht lange und erklärt Asteroid City kurzerhand zur Sperrzone. i
SONDERHALTESTELLE DOMPLATZ SÜD: Altstadt-Express, stündlich bis 15:30
BESUCHERZENTRUM ZITADELLE
PETERSBERG: Geheimnisvolle Wege durch die barocke Stadtfestung
11/14 ERFURT TOURIST INFO: Altstadtführung
11/14
SONDERHALTESTELLE DOMPLATZ SÜD: Erfurt-Tour: Fahrt mit der hist. Straßenbahn
14:00 DOM ST. MARIEN: Domführung
14:00 DOMPLATZ: Kulinarische Stadtführung
„Andreasviertel-Tour“ (Tel. 0361 /66 40 100)
14:00 WENIGEMARKT: Kulinarische Stadtführung
„Altstadt-Tour“ (Tel. 0361 /66 40 100)
17:30 BESUCHERZENTRUM ZITADELLE
PETERSBERG: Funzelführung mit Taschenlampen in den Horchgängen
31.7.–2.8., 16.50: Ernte teilen – Anders Ackern für die Zukunft (DE, 2023) Philipp Petruch ist überzeugt, dass die Klimakrise nur durch konkrete Lösungen überwunden werden kann. Er erzählt die Geschichten der Menschen, die sich bewusst für eine nachhaltige und gemeinschaftliche Landwirtschaft entschieden haben. Er will damit zeigen, dass jeder einzelne einen Beitrag leisten kann und dass es möglich ist, auf ökologische und soziale Weise Nahrungsmittel zu produzieren.
18:00
CAPONNIERE RESTAURANT IM EGAPARK: Weinwochen "Grillen & Wein"
20:00 ERFURT TOURIST INFORMATION: Romantischer Abendspaziergang…
49 Juli
DO 27.
TERMINE
KULTUR
11:00 KINOKLUB: Sommerferienkino
14:00 KINOKLUB: Sommerferienkino
16:30 KINOKLUB: Mit Liebe und Entschlossenheit (FR, 2022)
18:50 KINOKLUB: Asteroid City (USA, 2023)
19:30 HAUS DACHERÖDEN: Literaturdisko mit der Stadtschreiberin h
20:00 FORSTHAUS WILLRODA: Open Air: Mord im Morgengrauen
20:30 DOMPLATZ: DomStufen-Festspiele: Fausts Verdammnis – Oper von Hector Berlioz
20:30 NATURKUNDEMUSEUM: Der kleine Prinz –Unterwegs zu den Sternen (Tel. 66 40 120)
20:40 KINOKLUB: Die Unschärferelation der Liebe (DE, 2023)
21:00 ANGERMUSEUM: Der Glöckner von Notre Dame (Tel. 0361/66 40 100)
21:30 KULTURHOF KRÖNBACKEN: Open Air im Krönbacken: Sisi & ich (DE/CH/AT, 2023)
KIRCHE
12:00 AUGUSTINERKLOSTER: Friedensgebet
18:00 DOM ST. MARIEN: Abendmesse
FREIZEIT
06:30
08:30
DOMPLATZ: Frisch- und Hartwarenmarkt
MYTAOGARDEN AKADEMIE: FengShui Business

09:00 KULTURHOF KRÖNBACKEN: Workshop
10:00
10:30
11/15
„Farben für Alle – Action Painting“ – ab 11 J.
NATURKUNDEMUSEUM: Schlaumeierquiz
SONDERHALTESTELLE DOMPLATZ SÜD: Altstadt-Express – Fahrt mit dem Gelenkbus, stündlich bis 15:30 g
BESUCHERZENTRUM ZITADELLE
PETERSBERG: Geheimnisvolle Wege durch die barocke Stadtfestung
11/14 ERFURT TOURIST INFORMATION: Altstadtführung Erfurt – Die Faszination einer historischen Stadt erleben
11/14/16 SONDERHALTESTELLE DOMPLATZ SÜD: Erfurt-Tour: Fahrt mit der historischen
Straßenbahn
12/14/15 DOM ST. MARIEN: Glockenführung
13:00 DOM ST. MARIEN: Führungen zum Marienmosaik
14:00 DOM ST. MARIEN: Domführung
14:30 DOMPLATZ: Kulinarische Stadtführung
„Andreasviertel-Tour“ (Tel. 0361 /66 40 100)
14:30 WENIGEMARKT: Kulinarische Stadtführung
„Altstadt-Tour“ (Tel. 0361 /66 40 100)
16:00 ERFURT TOURIST INFORMATION: Kurzführung – Historische Altstadt
17:30 BESUCHERZENTRUM ZITADELLE
PETERSBERG: Funzelführung mit Taschenlampen in den Horchgängen
18:00 CAPONNIERE RESTAURANT IM EGAPARK: Weinwochen „Grillen & Wein“
18:00 MAISLABYRINTH: DJ Lounge Salsa Fiesta
18:00 ZITADELLE PETERSBERG: Rundgang mit dem Petersberger Schwarzbrenner (Tel: 66 40 100)
20:00 ERFURT TOURIST INFORMATION: Romantischer Abendspaziergang…
21:00 AUGUSTINERKLOSTER: Luthers schlaflose Nächte in Erfurt (Tel. 0361/66 40 120)
23:00 ENGELSBURG: 90's Baby
REGION
20:00 EISENACH/BURG CREUZBURG: Creedance
Clearwater Revived
ALTSTADT-EXPRESS – FAHRT MIT DEM GELENKBUS
Entdecken Sie Erfurt bequem vom Bus aus. Steigen Sie ein an der Sonderhaltestelle Domplatz Süd zu einer kurzen, faszinierenden Tour durch die mittelalterliche Erfurter Altstadt.

Mit einem kleinen wendigen Bus fahren Sie durch die engen Gassen, vorbei an Kirchen und geschichtsträchtigen Häusern. Unsere erfahrenen Stadtführer begleiten jede Tour persönlich.
Nach 45 Fahrminuten erreichen Sie wieder den Ausgangspunkt – Domplatz Süd.
April – Oktober/01.11.2023
Do – Sa 10.30 / 11.30 / 12.30 / 13.30 / 14.30 / 15.30 Uhr
50 JuliTERMINE 28. FR
Foto: Stadtverwaltung Erfurt
Foto: ETMG, B. Neumann
KULTUR
11:00 FESTUNGSBÄCKEREI: Open Air: Der Wolf und die 7 Geißlein
15:00 EGAPARK: Geschichten unterm Lesebaum
16:00 BARTHOLOMÄUSTURM: Juli-Livekonzert mit Jan-Sjörd van der Vaart aus Etten-Leur/NL
16:30 KINOKLUB: Mit Liebe und Entschlossenheit (FR, 2022)
18:00 JAZZCLUB: Erfurter Jazz Allstars mit der Holger-Arndt-Connexion h

18:50 KINOKLUB: Asteroid City (USA, 2023)
19:30 HAUS DACHERÖDEN: Marumba i
20:00 DASDIE LIVE: Travestie-Revue „Pretty Wo(man)“
20:00 FORSTHAUS WILLRODA: Open Air: Mord im Morgengrauen
20:30 DOMPLATZ: DomStufen-Festspiele: Fausts Verdammnis – Oper von Hector Berlioz
20:30 NATURKUNDEMUSEUM: Der kleine Prinz –Unterwegs zu den Sternen (Tel. 66 40 120)
20:40 KINOKLUB: Die Unschärferelation der Liebe
21:00 ANGERMUSEUM: Der Glöckner von Notre Dame (Tel. 0361/66 40 100)
21:00 KAUFMANNSKIRCHE: Sommernachtskonzert Vinzenz Heinze „Lieblingslieder“
21:30 EGAPARK: Sommerkino: Triangle of Sadness
21:30 KULTURHOF KRÖNBACKEN: Open Air Kino: Irgendwann werden wir uns alles erzählen
23:00 ENGELSBURG: All you can dance
KIRCHE
18:00 AUGUSTINERKIRCHE: Abendgebet mit Sonntagsbegrüßung
18:00 DOM ST. MARIEN: Vesper
18:00 KAUFMANNSKIRCHE: Abendsegen und Orgelmusik
FREIZEIT
06:30 DOMPLATZ: Frisch- und Hartwarenmarkt
10:00 MAISLABYRINTH: Familien Tag
10:00 NATURKUNDEMUSEUM: Schlaumeierquiz
10:15 ALTE SYNAGOGE: Öffentliche Führung
10:30 SONDERHALTESTELLE DOMPLATZ SÜD: Altstadt-Express – Fahrt mit dem Gelenkbus, stündlich bis 15:30
11:00 AUGUSTINERKLOSTER: Lebenslust und Seelenqualen – Luther in Erfurt (Tel. 66 40 120)
11/15 BESUCHERZENTRUM ZITADELLE
PETERSBERG: Geheimnisvolle Wege durch die barocke Stadtfestung
11:00 DOM ST. MARIEN: Turm- und Glockenführung, auch 12:00, 14:00, 15:00 und 16:00
11/14 ERFURT TOURIST INFORMATION: Altstadtführung Erfurt – Die Faszination einer historischen Stadt erleben
11/14/16 SONDERHALTESTELLE DOMPLATZ SÜD: Erfurt-Tour: Fahrt mit der historischen Straßenbahn
11:45 MIKWE: Öffentliche Führung
13:00 DOM ST. MARIEN: Öffentliche Führungen zum Marienmosaik
13/14 DOMPLATZ: Kulinarische Stadtführung
„Andreasviertel-Tour“ (Tel. 0361 /66 40 100)
13:30 WENIGEMARKT: Kulinarische Stadtführung „Altstadt-Tour“ (Tel. 66 40 100), auch 14:30
14:00 DOM ST. MARIEN: Domführung
14:00 STADTFARM AM KONTOR: Samenbomben rollen
14:30 DOMPLATZ: Kulinarische Stadtführung
„Erfurt macht blau“ (Tel. 0361 /66 40 100)
15:00 DOMSCHATZKAMMER: Führung
15:00 VINARIUM: Rundgang durch Aroma-Arena
16:00 ERFURT TOURIST INFORMATION: Kurzführung – Historische Altstadt
16:00 MESSE ERFURT: Nachtflohmarkt
17:00 DESTILLE: Brennereiführung
17:30 BESUCHERZENTRUM ZITADELLE
18:00
PETERSBERG: Funzelführung
MAISLABYRINTH: Sommer & Kinderfest

20:00 ERFURT TOURIST INFORMATION: Romantischer Abendspaziergang…
20:00 ILVERS: Karaoke Party
22:00 CLUB PALAIS: Ladies Night
REGION
10:30
WASSERBURG KAPELLENDORF: Open Air: Sterntaler
51
TERMINEJuli
SA 29.
AUSFLUGS-TIPP:
ABENTEUER REGENWALD
In einer Augmented Reality und live den Dschungel im Zoo Halle erleben

1.7.–31.8.2023, 9–19 Uhr, Bergzoo Halle
Unter dem Motto „Abenteuer Regenwald" präsentiert der Bergzoo Halle die erste interaktive Ausstellung mit der Flora und Fauna des Regenwalds, als Augmented Reality Erlebnis in einem deutschen Zoo. Mittels eures Handys und einer App, die man kostenlos herunterladen kann, sowie speziellen QR-Codes, erwachen die Bewohner des Dschungels direkt vor euren Augen zum Leben.
Erlebt 7 Dschungelbewohner, vom Tiger, über Gorilla bis hin zur Vogelspinne, eine Brandrodung und vieles mehr in einer realen Umgebung. Auf großen Infosäulen könnt ihr zudem spannende Videos zu den jeweiligen Tieren anschauen und in den vier Tropenhäusern des Bergzoo viele weitere Tiere des Regenwalds und Dschungelfeeling live erleben. Taucht also ein in diesen einzigartigen Lebensraum, mit dem größten Artenreichtum der Welt.
Dazu gibt es ein attraktives Rahmenprogramm mit Bogen -und Blasrohrschießen, Aktionsständen und Nachtführungen an den Wochenenden während der Sommerferien in Sachsen-Anhalt und als großes Highlight die Karibische Nacht am 12. August. Wenn ihr von eurer Regenwaldexpedition erschöpft seid, erwartet euch eine karibische Strandlandschaft mit Palmen, weißem Sandstrand, Bambushütten und Liegestühlen zum Entspannen
Mehr Informationen und Tickets auf www.zoo-halle.de
KULTUR
11:00 FORSTHAUS WILLRODA: Open Air: Sterntaler

11:00 STADTGARTEN: Open Air: Der gestiefelte Kater
16:30 KINOKLUB: Mit Liebe und Entschlossenheit (FR, 2022)
18:50 KINOKLUB: Asteroid City (USA, 2023)
20:30
DOMPLATZ: DomStufen-Festspiele: Fausts Verdammnis – Oper von Hector Berlioz
20:40 KINOKLUB: Die Unschärferelation der Liebe (DE, 2023)
KIRCHE
08:00 CRUCISKIRCHE: Hl. Messe
09:30 REGLERKIRCHE: Gottesdienst
09:30 ST. SEVERI: Hl. Messe
11/18 DOM ST. MARIEN: Gottesdienst
FREIZEIT
10:00 HEILIGEN MÜHLE: Großer Mühlentag h
10:00 MAISLABYRINTH: Familien Tag
10:00 NATURKUNDEMUSEUM: Schlaumeierquiz
10:30 SONDERHALTESTELLE DOMPLATZ SÜD: Altstadt-Express, stündlich bis 15:30
11/15 BESUCHERZENTRUM ZITADELLE
PETERSBERG: Geheimnisvolle Wege durch die barocke Stadtfestung
11/14 ERFURT TOURIST INFO: Altstadtführung
11/14 SONDERHALTESTELLE DOMPLATZ SÜD: Erfurt-Tour: Fahrt mit der hist. Straßenbahn
11:00 STADTMUSEUM: Offene Werkstatt
11:15 KUNSTHALLE: Führung durch die Ausstellung
„Engelberg+ Inszenierte Fotografie“
13/14 DOMPLATZ: Kulinarische Stadtführung
„Historische Sonntags-Tour“ (Tel. 66 40 100)
14:00 DOM ST. MARIEN: Domführung
14/15/16 DOM ST. MARIEN: Glockenführung
15:00
17:30
ERINNERUNGSORT TOPF & SÖHNE: Öffentliche Führung
BESUCHERZENTRUM ZITADELLE
PETERSBERG: Funzelführung mit Taschenlampen in den Horchgängen
REGION
20:00
WASSERBURG KAPELLENDORF:
Open Air: Go Papi Go
52 JuliTERMINE 30. SO
KULTUR
12:00 KAUFMANNSKIRCHE: 20 Min. Orgelmusik
16:50 KINOKLUB: Ernte teilen – Anders Ackern für die Zukunft (DE, 2023)
18:30 KINOKLUB: Mit Liebe und Entschlossenheit (FR, 2022)
20:50 KINOKLUB: Asteroid City (OmU, USA, 2023)
KIRCHE
18:00 DOM ST. MARIEN: Abendmesse
FREIZEIT
06:30 DOMPLATZ: Frischwarenmarkt
10:00 KULTURHOF KRÖNBACKEN: Workshop
„Sommerfilme für Alle – Klima und Wir“
10:00 MAISLABYRINTH: Biergarten&BrezelTag
10:00 STADTMUSEUM „HAUS ZUM STOCKFISCH“: Geocaching
11/15 BESUCHERZENTRUM ZITADELLE
PETERSBERG: Geheimnisvolle Wege durch die barocke Stadtfestung
11/14 ERFURT TOURIST INFORMATION: Altstadtführung Erfurt – Die Faszination einer historischen Stadt erleben
11:00 KAUFMANNSKIRCHE: Die Kaufmannskirche –ein verborgener Schatz
11/14
SONDERHALTESTELLE DOMPLATZ SÜD: Erfurt-Tour: Fahrt mit der historischen Straßenbahn
12:15 ELISABETHKAPELLE IM NIKOLAITURM: Führung in der Elisabethkapelle
14:00 DOM ST. MARIEN: Domführung
17:30 BESUCHERZENTRUM ZITADELLE
PETERSBERG: Funzelführung mit Taschenlampen in den Horchgängen der Zitadelle
VORSCHAU-TIPPS:
SASHA
THIS IS MY TIME
6.12.2023, 20 Uhr, Messehalle

Gemeinsam mit dem Regisseur Thomas Hermanns ist es ihm mit dem neuartigen Bühnenprogramm „This Is My Time – Die Show“ gelungen, eine Produktion zu erschaffen, die es in dieser Form in Deutschland noch nie gegeben hat:
Eine kurzweilige musikalische und humorvolle „One Man Show“, die die Zuschauer begeistern und berühren wird.
53
JuliTERMINE MO 31.
Tickets: (0361)66 40 100
Foto: Marco Meister
DH GEra
Premiere im Ekhof-Theater, Gotha*
Koproduktion Theater Waidspeicher und Thüringen Philharmonie Gotha-Eisenach 18:00 ab 10 Jahre Der Diener zweier Herren von Carlo Goldoni, in einer Spielfassung von Christian Georg Fuchs, mit Musik von Antonio Vivaldi, Johann Sebastian Bach und Heinrich Ignaz Franz Biber Puppentheater mit Barockorchester
im Ekhof-Theater,Gotha*
Premiere im Ekhof-Theater, Gotha*: Der Diener zweier Herren


12 Mi
ab 4
dem Roman von Peter Høeg in einer Bühnenfassung von Andreas Harwath Puppentheater
nach dem Märchen der Brüder Grimm Puppentheater


19:00 ab 10 Jahre Der Diener zweier Herren
im Ekhof-Theater,Gotha*
* Tickets für das Ekhof-Theater, Gotha sind im Ticket-Shop-Büro der Thüringen Philharmonie am Hauptmarkt 33 in 99867 Gotha, Telefon: 03621 751776, sowie online im Ticketshop Thüringen erhältlich.
www.ticketshop-thueringen.de
15 Sa 19:00 ab 10 Jahre
im Ekhof-Theater,Gotha*
16 So 11:00 ab 4 Jahre
17:00 ab 10 Jahre
im Ekhof-Theater,Gotha*
Diener zweier Herren
Diener zweier Herren
Vom 18. Juli bis 24. August 2023 hat das Theater Waidspeicher Theaterferien. Die Vorverkaufskasse ist bis 15. Juli und ab 15. August 2023 für Sie geöffnet. Wir wünschen allen Besuchern, Freunden und Förderern einen erholsamen Sommer!
Kartentelefon +49 (0)361 5982924 | kasse@waidspeicher.de | www.waidspeicher.de
der Vorverkaufskasse: Di bis Fr 10.00–14.00 Uhr & 15.00–17.30 Uhr | Sa 10.00–13.00 Uhr
2022 2023
Juli
Öffnungszeiten
Der
inkl. Pause von
Bulgakow Puppentheater/Schauspiel • • • • • • • • • • • • • • • • • • • • • • • • • • • • • • • • • • • • • • • • • • • • • • • • • • • • • • • • • • • • • 2 So 11:00 ab 6 Jahre Der standhafte Zinnsoldat nach dem Märchen von Hans Christian Andersen Puppentheater 3 Mo 10:00 ab 6 Jahre Der standhafte Zinnsoldat • • • • • • • • • • • • • • • • • • • • • • • • • • • • • • • • • • • • • • • • • • • • • • • • • • • • • • • • • • • • • 5 Mi 10:00 ab 6 Jahre Der standhafte Zinnsoldat • • • • • • • • • • • • • • • • • • • • • • • • • • • • • • • • • • • • • • • • • • • • • • • • • • • • • • • • • • • • • Vorstellungsänderung 6 Do 10:00 ab 4 Jahre Daumesdick nach dem Märchen der Brüder
Puppentheater
Fr 10:00 ab 4 Jahre Daumesdick
• • • • • • • • • • • • • • • • • • • • • • • • • • • • • • • • • • • • • • • • • • • • • • • • • • • • • • • • • • • • • 8 Sa 18:00 ab 10 Jahre Der Diener zweier Herren 9 So 11:00 ab 3 Jahre Der Maulwurf und die Sterne nach
Puppentheater 11 Di 19:30 ab 16 Jahre Fräulein Smillas Gespür für Schnee
Vorstellungsänderung 1 Sa 18:00 ab 16 Jahre
Meister und Margarita
Michail
Grimm
Vorstellungsänderung 7
dem Kinderbuch von Britta Teckentrup Uraufführung |
nach
• • • • • • • • • • • • • • • • • • • • • • • • • • • • • • • • • • • • • • • • • • • • • • • • • • • • • • • • • • • • •
Rumpelstilzchen
10:00
Jahre Daumesdick
10:00
Jahre Rumpelstilzchen
13 Do 10:00 ab 4 Jahre
14 Fr
ab 4
Der
Daumesdick
Der
• • • • • • • • • • • • • • • • • • • • • • • • • • • • • • • • • • • • • • • • • • • • • • • • • • • • •
Fotos: Lutz Edelhoff
• • • • • • • • • • • • • • • • • • • • • • • • • • • • • • • • • • • • • • • • • • • • • • • • • • • • •
Der standhafte Zinnsoldat
Der Maulwurf und die Sterne
Fräulein Smillas Gespür für Schnee
Juli
1 Sa 21:00 Mann mit Grill sucht Frau mit Kohle

3 Mo 19:30 Von der Pampelmuse geküsstDer Heinz-Erhardt-Abend
5 Mi 19:30 Geht´s noch!? - Best of BUB
6 Do 19:30 Es könnt‘ alles so einfach sein
7 Fr 21:00 Mann mit Grill sucht Frau mit Kohle
08 Sa 21:00 Liebe, Lust & Trallala

Wir haben Kabarettferien vom 09.07. -13.08.
NEU: Tickets gibt es ab sofort auch online unter: www.kabarett-diearche.de






KartenvorverKauf Öffnungszeiten Vorverkaufskasse Domplatz 18, 99084 Erfurt: Di – Fr: 10 –14 Uhr /15 –17:30 Uhr, Sa: 10 –13 Uhr www.kabarett-diearche.de / kasse@waidspeicher.de Telefon: 0361 ⁄ 598 29 24 / Telefax: 0361 ⁄ 598 29 23
VORSCHAU
Veranstaltungen
Tickets
und
Informationen
unter 0361 66 40 100
Siehe auch HIGHLIGHTS Seite 4
VORSCHAU 2023
11.8.2023 | Fr | 18.30
Fury in the Slaughterhouse – Hope Open Air

Central Park
12.8.2023 | Sa | 18.30
Madsen Central Park
18.8.2023 | Fr | 20.00
Roland Kaiser Domplatz
18.–20.8.2023 | Fr – So
Highfield Festival Großpösna bei Leipzig
19.8.2023 | Sa | 19.00
Broilers Domplatz
20.8.2023 | So | 19.30
10 Jahre Santiano Domplatz
25.8.2023 | Fr | 19.30
Andreas Gabalier Domplatz


25.8.2023 | Fr | 19.30
Project Unplugged Gustav-Adolf-Kirche
26./27.8.2023 | Sa/So | 18.30/18.00
Clueso Domplatz
1.9.2023 | Fr | 20.00
Götz Widmann Museumskeller
2.9.2023 | Sa | 18.00
Pyro Games 2023 Messehalle
2.9.2023 | Sa | 19.30
9. Molsdorfer Schloss Konzert: Londoner Trios
Schloss Molsdorf
5.9.2023 | Di | 20.00
Özcan Osar Alte Oper
7.9.2023 | Do | 19.30
Dr. Mark Benecke Alte Oper
8.9.2023 | Fr | 19.30
Petra Durst-Benning
Buchhandlung Peterknecht
9.9.2023 | Sa | 19.30
GlasBlasSing – Happy Hour
Kabarett Puffbohne
9.9.2023 | Sa | 19.30
Mary Roos & Wolfgang Trepper

Alte Oper
10.9.2023 | So | 19.30
Serdar Somuncu Alte Oper
13.9.2023 | Mi | 19.30
Dota Alte Oper
14./15.9.2023 | Do/Fr | 20.00
1. Sinfoniekonzert Theater Erfurt
56
ROLAND KAISER, Foto: Steffen Schmid
BROILERS, Foto: Robert Eikelpoth
CLUESO, Foto: Christoph Köstlin
MARY ROOS & WOLFGANG TREPPER, Foto: Th. Jander
15.9.2023 | Fr | 20.00
Bobby Alu Franz Mehlhose
16.9.2023 | Sa | 20.00
Ansa Sauermann & Band Museumskeller
18.9.2023 | Mo | 19.30
Element Of Crime Alte Oper
19.9.2023 | Di | 20.00
Timon Krause Haus Leipzig
20.9.2023 | Mi | 20.00
Erja Lyytinen Museumskeller
20.9.2023 | Mi | 20.00
Two Steps From Hell
QUARTERBACK Immpobilien ARENA Leipzig
21.9.2023 | Do | 19.30
Anna Loos Alte Oper
22.9.2023 | Fr | 19.30
Ingo Oschmann Kabarett Puffbohne
22.9.2023 | Fr | 20.00
Bastian Sick DasdieLive
23.9.2023 | Sa | 18.00
Die Schlagernacht des Jahres 2023 Messehalle
23.9.2023 | Sa | 19.30
AnNa R. Alte Oper
23.9.2023 | Sa | 20.00
Quatsch Comedy Club Dasdie Brettl

24.9.2023 | So | 18.00
Witz vom Olli Dasdie Brettl
24.9.2023 | So | 19.00
Ingmar Stadelmann Dasdie Live
27.9.2023 | Mi | 20.00
Roland Jankowsky liest …: Wenn Overbeck (wieder)kommt HsD
29.9.2023 | Fr | 20.00
Mr. Hurley & Die Pulveraffen HsD
30.9.2023 | Sa | 18.00
Antenne Thüringen – Das Konzert
Messehalle
30.9.2023 | Sa | 19.30
Gerard's Hypnoseshow Dasdie Brettl
30.9.2023 | Sa | 20.00
Die Herkuleskeule Dasdie Live
30.9.2023 | Sa | 20.00
The Doors in Concert HsD


6.10.2023 | Fr | 19.30
André Kudernatsch Buchhandlung Peterknecht

6.10.2023 | Fr | 20.00
UNIVERSUM25 – Horizont in Flammen HsD
Tickets und Informationen unter 0361 66 40 100 Veranstaltungen VORSCHAU
57
ELEMENT OF CRIME, Foto: Charlotte Goltermann
INGO OSCHMANN
ROLAND JANKOWSKY, Foto: Alexandra Kaumanns
THE DOORS IN CONCERT, Foto: Emile Vrolijk
VORSCHAU
Veranstaltungen
Tickets und Informationen unter 0361 66 40 100
6.10.2023 | Fr | 20.00
Renft Dasdie Brettl
6.10.2023 | Fr | 20.00
Tatjana Meissner Dasdie Live
6.10.2023 | Fr | 20.00
Adel Tawil Messehalle

6.10.2023 | Fr | 20.00
Engerling Museumskeller
7.10.2023 | Sa | 11.00
Hosenscheißer & Ladyfashion Flohmarkt Messehalle
7.10.2023 | Sa | 19.00
Alin Coen & STÜBAphilarmonie Theater Erfurt

7.10.2023 | Sa | 19.30
Smokie – The Legacy Tour 2023

Alte Oper
7.10.2023 | Sa | 19.30
10. Molsdorfer Schloss Konzert: MOZART! Schloss Molsdorf
7.10.2023 | Sa | 19.30
IC Falkenberg Dasdie Brettl
7.10.2023 | Sa | 20.00
30 Jahre Die Prinzen Messehalle
7.10.2023 | Sa | 20.00
Simon & Garfunkel Revival Band
Dasdie Brettl
8.10.2023 | So | 19.00
Nino de Angelo Messehalle
9.10.2023 | Mo | 19.00
Gregor Gysi – Ein Leben ist zu wenig Museumskeller
10.10.2023 | Di | 20.00
Sascha Lange: Depeche Mode live Dasdie Brettl

12.10.2023 | Do | 19.30
The Dark Tenor Alte Oper
12.10.2023 | Do | 20.00
Fabi Rommel Dasdie Brettl
12.10.2023 | Do | 20.00
Sophie Passmann Kaisersaal
12.10.2023 | Do | 20.00
Simon & Jan Museumskeller
58
ENGERLING, Foto: Anna Witzel
ADEL TAWIL
ALIN COEN, Foto: Sandra Ludewig
THE DARK TENOR, Foto: Alexandra Maria Sira
Stadtrundfahrten und Stadtführungen
Die Erfurt Tourismus & Marketing GmbH bietet regelmäßig zahlreiche
öffentliche Führungen an. Selbstverständlich organisieren wir für Sie ganzjährig auch Gruppenführungen entsprechend Ihren Bedürfnissen.
Für organisierte Führungen bitten wir um Voranmeldung:
Tel. 03 61/66 40-120 | citytour@erfurt-tourismus.de
Die Tickets für öffentliche Führungen sind online buchbar unter www.erfurt-tourismus.de oder können vorab in der Erfurt Tourist Information bzw. im Besucherzentrum auf dem Petersberg erworben werden. Rollstühle bzw. ein Rollator können in der Erfurt Tourist Information ausgeliehen werden.
Alle Angaben gelten vorbehaltlich der Entwicklung der pandemischen Situation.
STADTRUNDFAHRTEN
Um Vorabreservierungen wird gebeten.
Erfurt-Tour – Stadtrundfahrt mit der Straßenbahn im Tempo der Achtziger Jahre (1,5 h)
Januar – März Sa/So 11 und 14 Uhr
April – Okt. / 1.11.
täglich 11 und 14 Uhr/ zusätzlich Fr/Sa 16 Uhr
Nov. (4.– 26.11.) Sa/So 11 und 14 Uhr
28.11. – 22.12.
27.12. – 31.12.
täglich 11 und 14 Uhr/ zusätzlich Fr/Sa 16 Uhr
täglich 11 und 14 Uhr
Treffpunkt: Sonderhaltestelle Domplatz-Süd
Preise pro Person: 16 € ( bis 9 Pers.), 14 € (ab 10 Pers.), ermäßigt 8 €/mit ErfurtTravelCard 8 €, Familienkarte 40 € (2 Erw. + max. 4 Kinder im Alter von 6 – 16 Jahre)
Gruppenführung: Preis auf Anfrage
Altstadt-Express – Fahrt mit dem Gelenkbus (45 Minuten)
Treffpunkt: Sonderhaltestelle Domplatz Süd
Preis pro Person: 9 € (ermäßigt 6 €) / mit ErfurtTravelCard 6 €
Gruppenführung: 1 h – 295 € (deutsch) / 1 h – 315 € (Fremdsprache)
13:30, 14:30, 15:30 Uhr
(4.
25.11.) Sa 10:30, 11:30, 12:30, 13:30, 14:30, 15:30 Uhr 28.11. – 22.12. Mo – So 10:30, 11:30, 12:30, 13:30, 14:30, 15:30 Uhr
April – Okt. Do – Sa 10:30, 11:30, 12:30,
Nov.
bis
2023 www.erfurt-tourismus.de
STADTFÜHRUNGEN
Erfurt – die Faszination einer historischen Stadt erleben:
Die „Klassische“ (2 h)
Januar – März täglich 14 Uhr / zusätzlich jeden Sa/So 11 Uhr
April – Oktober täglich 11 und 14 Uhr
November täglich 14 Uhr / zusätzlich jeden Sa/So 11 Uhr
28.11. – 31.12.2023 täglich 11 Uhr und 14 Uhr
Treffpunkt: hinter der Erfurt Tourist Information (Benediktsplatz 1) am Till Eulenspiegel-Denkmal
Preis pro Person: 9 € (ermäßigt 6 €) / mit ErfurtCard kostenfrei
Gruppenführung 2h: 95 € (deutsch), 115 € (Fremdsprache)
Gruppenführung 1h: 80 € (deutsch), 100 € (Fremdsprache)
Die „Leichte“ (1,5 h)
April – Oktober Fr/Sa 16 Uhr
Treffpunkt: hinter der Erfurt Tourist Information (Benediktsplatz 1) am Till Eulenspiegel-Denkmal
Preis pro Person: 9 € (ermäßigt 6 €) / mit ErfurtCard kostenfrei
Romantischer Abendspaziergang mit Erfurter Weibsbildern oder dem Nachtwächter (2 h)
April – Oktober Do/Fr/Sa 20 Uhr
28.11.– 22.12.2023 Do/Fr/Sa 19 Uhr
Treffpunkt: hinter der Erfurt Tourist Information (Benediktsplatz 1) am Till Eulenspiegel-Denkmal
Preis pro Person: 10 € (ermäßigt 7 €) / mit ErfurtCard 7 €
Gruppenführung: 130 € (deutsch), 150 € (Fremdsprache)
PETERSBERG-FÜHRUNGEN
Geheimnisvolle Wege durch die barocke Stadtfestung (1 h)
Januar – März täglich 15 Uhr / zusätzlich Sa/So 11 Uhr
April – Dezember täglich 11 und 15 Uhr (24. – 26.12. / Neujahr bitte vorab informieren)
Treffpunkt: Kommandantenhaus – Ausstellung und Besucherzentrum
Preis pro Person: Erwachsener 7 € / Ermäßigt 4 €
Gruppenführung: 75 € (deutsch), 95 € (Fremdsprache)
Funzelführung mit Taschenlampen in den Horchgängen der Zitadelle Petersberg (1,5 h)
April – Dezember täglich 17:30 Uhr (24. – 26.12. / Neujahr bitte vorab informieren)
Treffpunkt: Kommandantenhaus – Ausstellung und Besucherzentrum
Preis pro Person: Erwachsener 12 € / Ermäßigt 7 €
Gruppenführung: 160 € (deutsch), 180 € (Fremdsprache)
Tel. 03 61/ 66 40-120 · citytour@erfurt-tourismus.de
13.10.2023 | Fr | 20.00
Ferdinand von Schirach Alte Oper
13.10.2023 | Fr | 20.00
LaBrassBanda Club Central
13.10.2023 | Fr | 20.00
Erwin Pelzig Dasdie Brettl
13.10.2023 | Fr | 20.00
Purple Schulz Dasdie Live
13.10.2023 | Fr | 20.00
Vanja Sky Museumskeller
14.10.2023 | Sa | 19.30
Max Uthoff Alte Oper
14.10.2023 | Sa | 20.00
Letz Zep HsD

14.10.2023 | Sa | 20.00
Tom Astor Dasdie Brettl

15.10.2023 | So | 19.00
Konstantin Wecker Alte Oper
18.10.2023 | Mi | 20.00
Sari Schorr Museumskeller
18.10.2023 | Mi | 20.00
Camouflage – Rewind To The Future And Goodbye Club Central


19.10.2023 | Do | 19.30
Naruto Symphonic Experience
QUARTERBACK Immobilien ARENA Leipzig
19.10.2023 | Do | 20.00
WAHNSINN! – Die beste Wolfgang Petry Party ist zurück Messehalle
19.10.2023 | Do | 20.00
Irina Titova - Queen of Sand – In 80 Bildern um die Welt Dasdie Brettl
20.10.2023 | Fr | 19.30
Christian Ehring Alte Oper
20.10.2023 | Fr | 20.00
Academixer – „Unter der Haube“ DasdieLive
20.10.2023 | Fr | 20.00
Ausbilder Schmidt Dasdie Brettl
21.10.2023 | Sa | 19.30
„Tan Caglar – Geht nicht? Gibt’s nicht!“
Kabarett Puffbohne
61 Tickets und Informationen unter 0361 66 40 100
Veranstaltungen VORSCHAU
LABRASSBANDA, Foto: David Königsmann
ERWIN PELZIG, Foto: Dita Vollmond
WAHNSINN!, Foto: Stefan Gregorowius
LETZ ZEP
VORSCHAU
Veranstaltungen
Tickets und Informationen unter 0361 66 40 100
21.10.2023 | Sa | 19.30
Scala & Kolacny Brothers Alte Oper
21.10.2023 | Sa | 20.00
Caveman Dasdie Brettl
21.10.2023 | Sa | 20.00
Go Big Or Go Home – The FMX Show by Luc Ackermann Messehalle

21.10.2023 | Sa | 20.00
Tanzbar – Renaissanceball
Theater Erfurt/Studio
22.10.2023 | S0 | 15.00
Conni – Das Zirkus-Musical Alte Oper
27.10.2023 | Fr | 19.30
Ute Freudenberg Alte Oper
27.10.2023 | Fr | 19.30
Falk Zenker Kultur: Haus Dacheröden
27.10.2023 | Fr | 20.00
Jan van Weyde Dasdie Live

28.10.2023 | Sa | 19.30
Ostrock meets Classic Alte Oper

28.10.2023 | Sa | 20.00
Keimzeit HsD
29.10.2023 | So | 19.00
Mathias Richling Dasdie Brettl
30.10.2023 | Mo | 19.30
Dance Masters! Best of Irish Dance
Kaisersaal
2.11.2023 |Do | 20.00
Lars Amend Dasdie Brettl

2.11.2023 |Do | 20.00
Zärtlichkeit mit Freunden Dasdie Live
3.11.2023 |Fr | 20.00
Red Hot Chilli Pipers feat. The Red Hot Chilli
Dancers HsD
4.11.2023 |Sa | 19.30
KARAT Alte Oper
4.11.2023 |Sa | 20.00
Staubkind HsD
4.11.2023 |Sa | 20.00
Ingo Appelt Dasdie Brettl
5.11.2023 |So | 15.00
Der Traumzauberbaum und Rosenhufs
Liebesbrille Alte Oper
5.11.2023 |So | 19.00
Ultimate Eagles Dasdie Brettl
62
LUC ACKERMANN, Foto: Jörg Mitter
FALK ZENKER, Foto: Peter Hoffmann
KARAT, Foto: Michael Petersohn
INGO APPELT, Foto: Ava Elderwood
WOHNMOBILSTELLPLATZ

„TOR ZUR STADT ERFURT“
Unweit der Messe Erfurt und des egaparks finden Sie den Wohnmobilstellplatz „Tor zur Stadt Erfurt“. Der ganzjährig betriebene kostenpflichtige Stellplatz wird ausschließlich Wohnmobilen vorbehalten. Der Standort nahe der Messe bietet idealen Anschluss zur Autobahn (A4, A71) und zum öffentlichen Nahverkehr in die Innenstadt. Nun wurde der Stellplatz mit dem Siegel „Top Platz“ ausgezeichnet.
Öffnungszeiten
täglich 08:30 – 17:30 Uhr
Check–out bis 12:00 Uhr



Check–in ab 13:00 Uhr
Stellplätze
· 48 Stellplätze in abgeschirmter
ruhiger Lage
· Parzellen 13x6 Meter mit Feinschotter befestigt
· Zufahrt durch Schranken geregelt
Informationen und Buchung
Anschrift:
Gothaer Straße 30, 99094 Erfurt
Telefon: +49 361 65 31 48 20
E-Mail: info@erfurt–wohnmobil.de
www.erfurt–wohnmobil.de
Busparkplatz
Der Busparkplatz mit gemütlicher Busfahrer–Lounge bietet insgesamt 51 Stellplätze und wird von der ETMG betrieben. Das Nutzen der Busstellplätze ist gebührenpflichtig und nur mit gültigem Parkschein gestattet. Die Parkgebühren werden von den Busfahrern in der Rezeption entrichtet.

Öffentliche Toiletten
Im vorderen Bereich des Gebäudes befinden sich öffentliche und eine behindertengerechte Toilette, die mit Euro–WC-Schlüssel zu öffnen ist.
VORSCHAU
Veranstaltungen
Tickets und Informationen unter 0361 66 40 100
5.11.2023 |So | 19.00
ABBA – The Tribute Concert Messehalle

7.11.2023 |Di | 20.00
Dittsche Alte Oper
8.11.2023 | Mi | 19.30
Schwarze Augen – Eine Nacht im Russenpuff
Alte Oper
8.11.2023 | Mi | 20.00
SELIG – 30 Jahre und endlich unendlich HsD
8.11.2023 | Mi | 20.00
Ben Poole Museumskeller
9.11.2023 |Do | 20.00
Lina Maly – Live 2023 Engelsburg
9.11.2023 |Do | 20.00
Stoppok HsD
10.11.2023 | Fr | 20.00
Let’s Dance – Die Live-Tournee 2023
QUARTERBACK Immobilien ARENA Leipzig
10.–12.11.2023 |Fr – So | 10.00
Haus.Bau.Ambiente. Messehalle
11.11.2023 | Sa | 19.30
die feisten Alte Oper
SELIG
DIE FEISTEN
11.11.2023 | Sa | 20.00
Pothead HsD
11.11.2023 | Sa | 20.00
Barock Club Central
11./12.11.2023 | Sa/So
StyleCom Messehalle
12.11.2023 | So | 18.00
Spider Murphy Gang – Unplugged Alte Oper



14.11.2023 | Di | 19.30
Dr. Daniele Ganser Alte Oper
15.11.2023 | Mi | 20.00
EMMVEE – M wie Comedy Dasdie Brettl
17.11.2023 | Fr | 19.30
Sven Bensmann – YES WE SVEN
Kabarett Puffbohne
17.11.2023 | Fr | 20.00
Michael Hatzius – Echsoterik
Dasdie Brettl
17.11.2023 | Fr | 20.00
Alligathoa Messehalle
18.11.2023 | Sa | 19.30
Christian Schulte-Loh Kabarett Puffbohne SPIDER MURPHY GANG
64
ABBA – The Tribute Concert, Foto: Andreas Leber
18.11.2023 | Sa | 19.30
Tanzwut HsD
18.11.2023 | Sa | 20.00
Guitar Wolf Museumskeller
22.11.2023 | Mi | 20.00
The Dublin Legends Thomaskirche
22.11.2023 | Mi | 20.00
Annett Louisan Messehalle
23.11.2023 | Do | 20.00
Kerstin Ott Messehalle
23.11.2023 | Do | 20.00
Aynsley Lister Museumskeller
23.11.2023 | Do | 20.00
Maite Kelly

QUARTERBACK Immobilien ARENA Leipzig
24.11.2023 | Fr | 20.00
Mario Barth Messehalle
27.11.2023 | Mo | 19.30
Dresdner Kreuzchor Alte Oper
28.11.2023 | Di | 20.00
Fehlfarben Kalif Storch
1.12.2023 | Fr | 19.30
May Ray Show Kabarett Puffbohne
1.12.2023 | Fr | 20.00
Ralf Schmitz – Schmitzefrei Messehalle
2.12.2023 | Sa | 19.30
Schwarze Grütze Kabarett Puffbohne
2.12.2023 | Sa | 19.30
Herr Schröder Alte Oper
2.12.2023 | Sa | 20.00
Sarah Connor Messehalle
5.12.2023 | Di | 20.00
Night of the Proms Messehalle
6.12.2023 | Mi | 20.00
Sasha Messehalle
7.12.2023 | Do | 19.30
Fabio Landert – Unter die Haut

Kabarett Puffbohne
8.12.2023 | Fr | 19.30
Dirk Michaelis Kabarett Puffbohne

8./9.12.2023 | Fr/Sa | 20.00

Die Art Musemskeller
9.12.2023 | Sa | 20.00
Söhne Hamburgs – Endlich wieder
Weihnachten! Alte Oper
65 Tickets und Informationen unter 0361 66 40 100
Veranstaltungen VORSCHAU
RALF SCHMITZ
KERSTIN OTT, Foto: Nona Arabuli
MARIO BARTH, Foto: Sebastian Drueen
SARAH CONNOR, Foto: Paul Hüttemann
VORSCHAU Veranstaltungen
Tickets und Informationen unter 0361 66 40 100
11.12.2023 | Mo | 20.00
Mike Singer Täubchenthal Leipzig
13.12.2023 | Mi | 19.30
Uwe Steimle Alte Oper
15.12.2023 | Fr | 19.30
The 12 Tenors Alte Oper

15./16.12.2023 | Fr/Sa | 19.30
Fack Ju Göhte – Das Musical Messehalle
16.12.2023 | Sa | 19.30
Sybille Bullatschek Kabarett Puffbohne

16.12.2023 | Sa | 20.00
Wolf Maahn & Band HsD
22.12.2023 | Fr | 19.30
Ute Freudenberg Alte Oper
26.12.2023 | Di | 18.00
11. Molsdorfer Schloss Konzert: Weihnachtskonzert des Kammermusikvereins Erfurt
Schloss Molsdorf
31.12.2023 | So | 16.30
Felix Reuter – Die verflixte Klassik

Kaisersaal
31.12.2023 | So | 19.00
Nussknacker on Ice Messehalle
VORSCHAU 2024
1.1.2024 | Mo | 16.00
Traditionelles Neujahrskonzert
Kaisersaal
6.1.2024 | Sa | 14.30/19.30
Musikparade 2024 Messehalle
6.1.2024 | Sa | 19.30
Ulrich Tukur & Die Rhythmus Boys Alte Oper
11.1.2024 | Do | 20.00
König der Löwen – Live in Concert
Messehalle
13./14.1.2024 | Sa/So | 19.00/11.00
Ehrlich Brothers – Dream & Fly Messehalle

27.1.2024 | Sa | 19.30
Der Nussknacker – Klassik trifft auf Breakdance
Alte Oper
27.1.2024 | Sa | 20.00
Markus Maria Profitlich Dasdie Brettl
28.1.2024 | So | 15.00
Die Schneekönigin – Das Musical Kaisersaal
31.1.2024 | Mi | 20.00
Alphaville – The Symphonic Tour
Messehalle
66
UTE FREUDENBERG
FELIX REUTER
ALPHAVILLE, Foto: Helen Sobiralski
EHRLICH BROTHERS, Foto: Ralph Larmann
2.2.2024 | Fr | 19.30
Eure Mütter Alte Oper
3.2.2024 | Sa | 19.30
Yves Macak – R-zieher sind Superhelden!
Kabarett Puffbohne
3.2.2024 | Sa | 20.00
Martin Rütter Messehalle
4.2.2024 | So | 18.00
Die Eiskönigin – Die Musik-Show auf Eis Messehalle
9.2.2024 | Fr | 20.00
Der Herr der Ringe & Der Hobbit & Die Ringe der Macht – Das Konzert Messehalle
24.2.2024 | Sa | 20.00
Wolfgang Trepper Dasdie Brettl

25.2.2024 | So | 19.30
Ben Becker – Affe Alte Oper
2.3.2024 | Sa | 20.00
André Herrmann – Roast in Peace
Dasdie Brettl
7.3.2024 | Do | 20.00
Mirja Regensburg – HAPPY. Dasdie Brettl
9.3.2024 | Sa | 20.00
Chinesischer Nationalcircus – China Girl
Messehalle
10.3.2024 | So | 19.00
Sascha Grammel – Wünsch dir was Messehalle
16.3.2024 | Sa | 20.00
Nicole Jäger – Walküre Dasdie Brettl
29.4.2024 | Mo | 20.00
Dirty Dancing in Concert Messehalle
10.5.2024 | Fr | 20.00
Lord of the Dance Messehalle
11.5.2024 | Sa | 20.00
The Show – A Tribute to ABBA
Messehalle
17.5.2024 | Fr | 20.00
Howard Carpendale – Live – Das ist mein Leben!


Messehalle
19.5.2024 | So | 20.00
Mark Forster Messehalle
12.9.2024 | Do | 20.00
Jürgen von der Lippe – VOLL FETT Alte Oper

31.10.2024 | Do | 20.00
Bülent Ceylan – Yallah hopp! Alte Oper
67 Tickets und Informationen unter 0361 66 40 100 Veranstaltungen VORSCHAU
MARTIN RÜTTER, Foto: Klaus Grittner
SASCHA GRAMMEL
JÜRGEN VON DER LIPPE, Foto: Andre Kowalski
ANDRÉ HERRMANN, Foto: Guido Schröder
13,90 € TravelCard ErfurtCard Ihr 48 Stunden-Erlebnisticket Weitere Informationen in der ERFURT TOURIST INFORMATION Nutzen Sie die Vorteile! ERFURTTRAVELCARD Erfurt Tourismus und Marketing GmbH oder 19,90 € 21,90




Jetzt Guthaben bis 250 Euro aufladen und individuell bei allen Akzeptanzstellen abbuchen. Zu erwerben in der Erfurt Tourist Information Benediktsplatz 1, 99084 Erfurt oder online unter: Der beliebte Erfurt-Gutschein w w w . e r f u r t - g u t s c h e i n . d e
VERANSTALTUNGSORTE
KULTUR
Alte Oper Theaterstr. 1, T. 55 11 66
Andreas Kavalier Andreasstr. 45, T. 2 11 91 40
Atelier Puppenspiel Leipziger Str. 15, T. 64 64 790
Bibliothek Domplatz 1, T. 6 55 15 90
Bibliothek Kinder/Jugend Marktstr. 21, T. 6 55 15 95
Central Club Am Wasserturm 8–10
CineStar Hirschlachufer 7, www.cinestar.de
Club From Hell Erfurt–Bindersleben, Flughafenstr.
Cosmopolar Anger 66, T. 64 47 62 60
Dasdie Brettl/Kabarett Puffbohne Lange Brücke 29/
Dasdie Live Marstallstr. 12, T. 55 11 66
Destille An der Martinsbastion, T. 64 43 66 00

Eburg Club Allerheiligenstr. 20/21, T. 24 47 70
egapark Gothaer Str. 38, T. 5 64 37 37
Franz Mehlhose Löberstr.12, www.franz-Mehlhose.de
Füchsen Hütergasse 13, T. 6 44 14 48
Galli Theater Erfurt Marktstr. 35, T. 34 19 45 24
HAUS DACHERÖDEN Anger 37, T. 64 41 23 75
Heiligen Mühle Mittelhäuser Str. 16, T. 73 32 97
Himmelspforte Marktstr. 6, T. 0177/5 98 62 60
HsD Juri–Gagarin-Ring 150, T. 5 62 49 94
Jazzclub Erfurt e.V. www.jazzclub-erfurt.de
Kaisersaal Futterstr. 15/16, T. 5 68 81 23
Kabarett „Die Arche“ Domplatz 18, T. 5 98 29 24
Kabarett Lachgeschoss Futterstr. 13, T. 6 63 58 86
Kalif Storch Zum Güterbahnhof 20, T. 4 30 67 30
Kinoklub Hirschlachufer 1, T. 6 42 21 94
Klanggerüst Magdeburger Allee 175
Kleine Synagoge An der Stadtmünze 4/5, T. 6 55 16 60
Kontor Hugo–John-Str. 8, www.kontor-erfurt.de
KulturQuartier Schauspielhaus. Klostergang 4
Messe Erfurt GmbH Gothaer Str , T. 4 00–0
Museumskeller Juri–Gagarin-Ring 140 a, T. 5 62 49 94
Musikpark Willy–Brandt–Platz 1, T. 5 50 40 82
Nerly Marktstr. 6, T. 3 81 32 55
Presseklub Dalbergsweg 1, T. 7 89 45 65
Stadtgarten Dalbergsweg 2, T. 55 11 66
Theater Erfurt P.-Muth-Str. 1, T. 22 33 –155
Theater Die Schotte Schottenstr. 7, T. 6 43 17 22
Theater im Palais Michaelisstr. 30, T. 55 04 99 01
Theater Waidspeicher Domplatz 18, T. 5 98 29 24
Thüringenhalle W.-Seelenbinder-Str. 2, T. 3 73 60 43
Weinmanufaktur/Vinarium Petersberg 8, T. 64 43 66 00
KIRCHEN
Dom St. Marien Domstufen 1, T. 6 46 12 65
Augustinerkloster (Luther–Gedenkstätte/ Tagungsheim), Augustinerstr. 10, T. 5 76 60 10
Kaufmannskirche Anger, T. 26 26 962
Michaeliskirche Allerheiligenstr., T. 6 42 20 90
Predigerkirche Meister-Eckehardt-Str., T. 562 62 14
Reglerkirche Bahnhofstr. 7, T. 562 98 62
Thomaskirche Puschkinstr. 11a, T. 345 62 64
SPORT
Eissportzentrum Arnstädter Str. 53, T. 6 55 46 95
Matthes Schwimmhalle J.-S.–Bach-Str. 6, T. 5 64 35 30
Tourist
Meiningen Ernestinerstr.2, T. 03693/4 46 50
Tourist Info Mühlhausen Ratsstr. 20, T. 03601/40 47 70
Tourist Info Oberhof Crawinkler Str. 2, T. 036842/26 90
Tourist Info Rudolstadt Marktstr. 5, T. 03672/48 64 40
Tourist Info Saalfeld Markt 10, T. 03671/52 21 81
Tourist Info Schmalkalden AuerGasse 6–8, T. 03683/6097580
Tourist Info Sondershausen Markt 9, T. 03632/78 81 11
Tourist Info Suhl Friedrich-König-Str. 7, T. 03681/78 84 05
Tourist Info Weimar Markt 10, T. 03643/745–0
DNT Weimar Theaterplatz 2, T. 03643/75 53 34
Schlosstheater Arnstadt Schlossgarten, T. 03628/61 86 33
Theater Meiningen Bernhardstr. 5, T. 03693/45 21 22
Avenida Therme Hohenfelden Am Stausee 1, T. 036450/44 90
TICKETS
ERFURT TOURIST INFORMATION
Benediktsplatz 1 (zwischen Rathaus und Krämerbrücke) Mo-Sa 10–18 Uhr ·
Tel. 0361/66 40 100, Fax 0361/66 40 280 tickets@erfurt-tourismus.de www.erfurt-tourismus.de
Besucherzentrum Zitadelle Petersberg
Petersberg 3
Mo-So 10–18 Uhr
Tel. 0361/66 40 170 info@petersberg-erfurt.de www.petersberg-erfurt.de
70
Leichtathletikhalle J.-S.–Bach-Str. 2, T. 6 55 46 20/21
Roland
Riethstr.
Riethsporthalle Essener Str. 20, T. 7 92 14 02 Steigerwaldstadion Arnstädter Str. 55, T. 6 55 46 20/21 FC Rot–Weiß Erfurt Arnstädter Str. 28, T. 34 76 60 Thüringenhalle Werner-Seelenbinder-Str. 2, T.
REGION Tourist Info Altenburg Markt 17, T. 03447/51 28 00 Tourist Info Apolda Markt 1, T. 03644/65 01 00 Tourist Info Arnstadt Markt 1, T. 03628/60 20 49 Tourist Info Eisenach Markt 24, T. 03691/7 92 30 Tourist Info Gotha Hauptmarkt 33, T. 03621/51 04 50 Tourist Info Ilmenau Am Markt 1, 03677/60 03 00 Tourist Info Jena Markt 16, T. 03641/49 80 50
Schwimmhalle Johannesplatz F.-Engels-Str. 50, T. 5 64 35 00 Radrennbahn Andreasried
29 a, T. 7 31 88 75 10
3 73 60 43
Info




www.petersberg-erfurt.de PETERS BERG FEST Auf zur Stadtkrone! 01.07.23 10–18 Uhr















































www.zoo-halle.de 01.07. 31.08. 2023 BERGZOO HALLE Regenwald live und in einer Augmented Reality Mit freundlicher Unterstützung von: –Mit Bogen -und Blasrohrschießen Papageien-Rallye mit tollen Preisen Karibische Nacht am SA 12.08.





























































 Foto: ETMG, S. Bauerschmidt
Foto: ETMG, S. Bauerschmidt
Foto: ETMG, S. Bauerschmidt
Foto: ETMG, S. Bauerschmidt